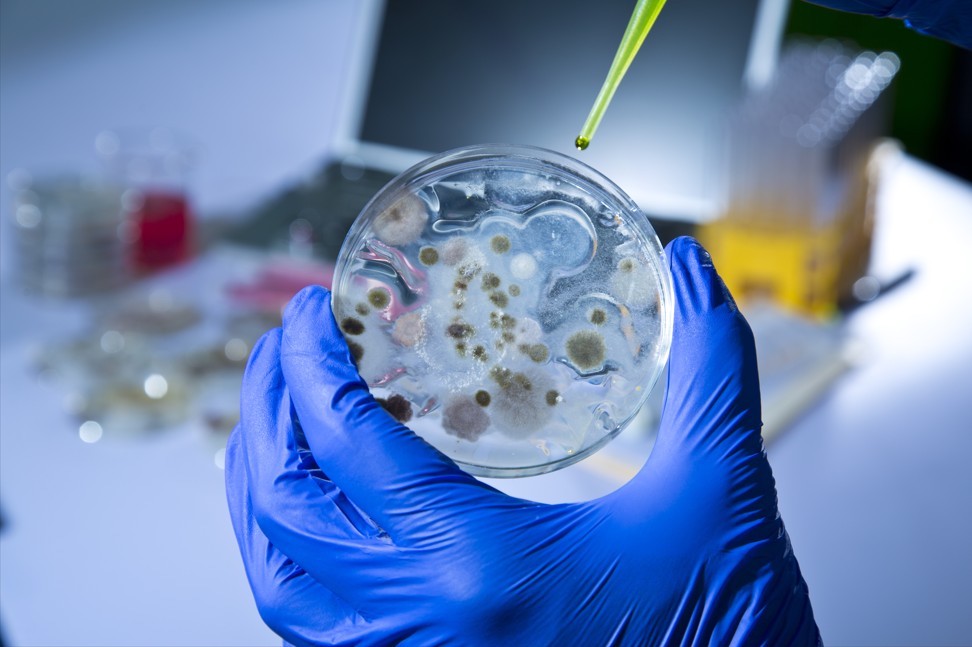

Channels
Special Offers & Promotions
AMS Biotechnology (Europe) Ltd
Products
Contact AMS Biotechnology (Europe) Ltd
All articles from AMS Biotechnology (Europe) Ltd
Europa Biosite Announces Exclusive UK & Ireland Partnership between Bio X Cell and Cambridge Bioscience
Sep 23, 2025
Integrating matrix into 3D spheroid culture enables high throughput measurement of cell invasion
Jan 21, 2013
Investigating protein-binding properties of Heparin, Heparan Sulfate and other glycosaminoglycans (GAGS)
Sep 12, 2011
Media Partners

SoluLyse™ from Amsbio is a bacterial protein extraction reagent that provides a highly efficient yet gentle method for extracting soluble proteins from bacterial cells. Based upon a proprietary non-ionic detergent formulation, with the SoluLyse™ reagent there is no need for time-consuming and cumbersome secondary treatment methods such as sonication or freeze thaw. The unique, mild SoluLyse™ formulation allows perforation of bacterial cell walls without denaturing proteins...
SoluLyse™ from Amsbio is a bacterial protein extraction reagent that provides a highly efficient yet gentle method for extracting soluble proteins from bacterial cells. Based upon a proprietary non-ionic detergent formulation, with the SoluLyse™ reagent there is no need for time-consuming and cumbersome secondary treatment methods such as sonication or freeze thaw. The unique, mild SoluLyse™ formulation allows perforation of bacterial cell walls without denaturing proteins... Amsbio offers a wide selection of over 325,000 pre-characterized chemical compounds to support your drug screening applications for discovery and development. From individual inhibitors, agonists and natural products to ready-to-screen compound libraries, these cost-effective, high-quality reagents are perfect for both academic and industrial research...
Amsbio offers a wide selection of over 325,000 pre-characterized chemical compounds to support your drug screening applications for discovery and development. From individual inhibitors, agonists and natural products to ready-to-screen compound libraries, these cost-effective, high-quality reagents are perfect for both academic and industrial research... Europa Biosite is pleased to announce that Bio X Cell has appointed Cambridge Bioscience, a proud member of Europa Biosite, as its exclusive distributor for the United Kingdom and Ireland. This strategic partnership ensures that researchers across the UK and Ireland will have streamlined access to the Bio X Cell portfolio which features best-in-class functional monoclonal antibodies, globally recognized for their high quality, purity, and consistency...
Europa Biosite is pleased to announce that Bio X Cell has appointed Cambridge Bioscience, a proud member of Europa Biosite, as its exclusive distributor for the United Kingdom and Ireland. This strategic partnership ensures that researchers across the UK and Ireland will have streamlined access to the Bio X Cell portfolio which features best-in-class functional monoclonal antibodies, globally recognized for their high quality, purity, and consistency... Amsbio reports how the Sasaki Lab within the School of Veterinary Medicine at the University of Pennsylvania (USA) devised a protocol in which induced pluripotent stem cells (iPSCs) could be utilized to produce reconstituted human testes. Since the original 2020 publication of their groundbreaking research, Dr Kotaro Sasaki’s team has made significant progress in reconstituting human testis-like tissue from iPSCs...
Amsbio reports how the Sasaki Lab within the School of Veterinary Medicine at the University of Pennsylvania (USA) devised a protocol in which induced pluripotent stem cells (iPSCs) could be utilized to produce reconstituted human testes. Since the original 2020 publication of their groundbreaking research, Dr Kotaro Sasaki’s team has made significant progress in reconstituting human testis-like tissue from iPSCs... Amsbio has launched a new range of Deubiquitinating (DUB) enzyme assay kits supplied in a convenient and easy-to-use 96-well assay format. With minimal setup required and no need for substrate preparation, these ready-to-use kits accelerate routine DUB activity assays without compromising data quality. Ubiquitination and deubiquitination are two important physiological processes in the ubiquitin-proteasome system, responsible for protein degradation in cells...
Amsbio has launched a new range of Deubiquitinating (DUB) enzyme assay kits supplied in a convenient and easy-to-use 96-well assay format. With minimal setup required and no need for substrate preparation, these ready-to-use kits accelerate routine DUB activity assays without compromising data quality. Ubiquitination and deubiquitination are two important physiological processes in the ubiquitin-proteasome system, responsible for protein degradation in cells... AMSBIO announces a new range of ready-to-use Human induced Pluripotent Stem Cell (hiPSC) -derived cardiomyocytes, hepatocytes, and neurons. Supplied fully differentiated and available in high-purity formats, these ready-to-use cells help accelerate research by streamlining lab workflows, eliminating the need for in-house differentiation and minimizing preparation time...
AMSBIO announces a new range of ready-to-use Human induced Pluripotent Stem Cell (hiPSC) -derived cardiomyocytes, hepatocytes, and neurons. Supplied fully differentiated and available in high-purity formats, these ready-to-use cells help accelerate research by streamlining lab workflows, eliminating the need for in-house differentiation and minimizing preparation time... AMSBIO has implemented a program of investment to support the students at Penn State Lehigh Valley, part of Pennsylvania State University, in their transformative Course-based Undergraduate Research Experience (CURE) program. The CURE program, led by Dr. Jacqueline McLaughlin, allows students to dive into real-world research projects that tackle critical challenges in health and medicine...
AMSBIO has implemented a program of investment to support the students at Penn State Lehigh Valley, part of Pennsylvania State University, in their transformative Course-based Undergraduate Research Experience (CURE) program. The CURE program, led by Dr. Jacqueline McLaughlin, allows students to dive into real-world research projects that tackle critical challenges in health and medicine... EZ-Spread™ Plating Beads from AMSBIO allow you to spread bacterial and yeast cells across the surface of an agar plate in just seconds. Eliminating the traditional need for glass rods and potentially hazardous ethanol flaming - EZ-Spread plating beads provide a safer and more convenient method for spreading bacterial and yeast cells on agar plates. Manufactured using precision molds, resulting in uniform shape and diameter, EZ-Spread plating beads ensure more even spreading of cells leading to...
EZ-Spread™ Plating Beads from AMSBIO allow you to spread bacterial and yeast cells across the surface of an agar plate in just seconds. Eliminating the traditional need for glass rods and potentially hazardous ethanol flaming - EZ-Spread plating beads provide a safer and more convenient method for spreading bacterial and yeast cells on agar plates. Manufactured using precision molds, resulting in uniform shape and diameter, EZ-Spread plating beads ensure more even spreading of cells leading to... AMSBIO announce a new range of Synthetic Nanodiscs that enable preparation of multi-pass transmembrane proteins in their active form, revolutionizing the future of membrane protein research and drug development. Membrane Proteins account for more than 60% of all FDA-approved drug targets and 90% of antibody-based drug targets. Many traditional sample preparation methods struggle with challenges in obtaining water-soluble and bioactive forms of multi-pass transmembrane proteins...
AMSBIO announce a new range of Synthetic Nanodiscs that enable preparation of multi-pass transmembrane proteins in their active form, revolutionizing the future of membrane protein research and drug development. Membrane Proteins account for more than 60% of all FDA-approved drug targets and 90% of antibody-based drug targets. Many traditional sample preparation methods struggle with challenges in obtaining water-soluble and bioactive forms of multi-pass transmembrane proteins... AMSBIO has launched CellO-IF – an all-in-one immunofluorescent staining reagent kit designed to accelerate the labelling organoids and spheroids directly in hydrogels or extracellular matrices, while preserving delicate structures and cellular integrity. Immunofluorescence (IF) allows detection and localization of antigens in diverse types of tissues in various cell preparations. The technique provides excellent sensitivity and amplification of signal by comparison to immunohistochemistry...
AMSBIO has launched CellO-IF – an all-in-one immunofluorescent staining reagent kit designed to accelerate the labelling organoids and spheroids directly in hydrogels or extracellular matrices, while preserving delicate structures and cellular integrity. Immunofluorescence (IF) allows detection and localization of antigens in diverse types of tissues in various cell preparations. The technique provides excellent sensitivity and amplification of signal by comparison to immunohistochemistry... BioPORTER® protein delivery reagent from AMSBIO is proven to efficiently transport functionally active proteins directly into living cells eliminating the traditional DNA transfection, transcription, and protein translation process. Employing a unique lipid-based protein delivery system – BioPORTER® makes studying protein functionality faster and easier than ever before...
BioPORTER® protein delivery reagent from AMSBIO is proven to efficiently transport functionally active proteins directly into living cells eliminating the traditional DNA transfection, transcription, and protein translation process. Employing a unique lipid-based protein delivery system – BioPORTER® makes studying protein functionality faster and easier than ever before... The MycoScope™ Mycoplasma PCR detection kit from AMSBIO uses polymerase chain reaction (PCR) technology to detect mycoplasma infections in less than 3 hours. Offering high-sensitivity detection, rapid results, and compatibility with existing PCR setups, this kit reduces the risk of contamination spread saving valuable time and resources. As reported in the ISSCR standards report (2023) a sizeable proportion of cell cultures (up to >80%) are infected with mycoplasma...
The MycoScope™ Mycoplasma PCR detection kit from AMSBIO uses polymerase chain reaction (PCR) technology to detect mycoplasma infections in less than 3 hours. Offering high-sensitivity detection, rapid results, and compatibility with existing PCR setups, this kit reduces the risk of contamination spread saving valuable time and resources. As reported in the ISSCR standards report (2023) a sizeable proportion of cell cultures (up to >80%) are infected with mycoplasma... AMSBIO has launched a range of genetically engineered Induced Pluripotent Stem Cells (iPSCs) developed to provide improved model fidelity over cell lines and biochemical assays used for drug discovery and cell therapy research. These iPSC cell lines offer improved efficiency and cost savings compared to animal models, enhancing high-throughput reporter lines, human disease models and toxicity screening.
AMSBIO has launched a range of genetically engineered Induced Pluripotent Stem Cells (iPSCs) developed to provide improved model fidelity over cell lines and biochemical assays used for drug discovery and cell therapy research. These iPSC cell lines offer improved efficiency and cost savings compared to animal models, enhancing high-throughput reporter lines, human disease models and toxicity screening. AMSBIO offers a range of kits, media and reagents enabling development of food in a way that is not wasteful of our natural resources and is not detrimental to the environment or consumer health. Recent advances in biotechnological methods have enabled the development of cultured meat - meat grown in a laboratory using stem cell technology that mimics the texture, flavor, and nutritional value of conventional meat...
AMSBIO offers a range of kits, media and reagents enabling development of food in a way that is not wasteful of our natural resources and is not detrimental to the environment or consumer health. Recent advances in biotechnological methods have enabled the development of cultured meat - meat grown in a laboratory using stem cell technology that mimics the texture, flavor, and nutritional value of conventional meat... AMSBIO, a leading provider of innovative products and services for the life sciences community, announces the launch of its Expanded Stem Cell Synergy Solutions. Over the last two decades AMSBIO has established itself as a leading international supplier of solutions for streamlined and efficient ES/iPS Cell Culture using feeder-free StemFit® media and iMatrix recombinant laminin extracellular matrices...
AMSBIO, a leading provider of innovative products and services for the life sciences community, announces the launch of its Expanded Stem Cell Synergy Solutions. Over the last two decades AMSBIO has established itself as a leading international supplier of solutions for streamlined and efficient ES/iPS Cell Culture using feeder-free StemFit® media and iMatrix recombinant laminin extracellular matrices... CELLBANKER® freezing media from AMSBIO is now available in customizable formats, seamlessly integrating into cell manufacturing processes with personalized formulations, volumes, and packaging. Cited in over 500 scientific publications, the CELLBANKER range has proven itself as a safe and reliable solution for storing cells and tissues. This includes GMP-grade, chemically defined formulations specifically designed for the storage of biospecimens for clinical applications...
CELLBANKER® freezing media from AMSBIO is now available in customizable formats, seamlessly integrating into cell manufacturing processes with personalized formulations, volumes, and packaging. Cited in over 500 scientific publications, the CELLBANKER range has proven itself as a safe and reliable solution for storing cells and tissues. This includes GMP-grade, chemically defined formulations specifically designed for the storage of biospecimens for clinical applications... AMSBIO has launched a new 2024 travel grant award scheme for scientists under the age of thirty, employed in academia, research institutions, or companies engaged in cancer and stem cell research. Working closely with the global life science community for over three decades AMSBIO believes in partnership and paying back by supporting new research and researchers. Last year, the company funded a travel grant to attend ISSCR 2023...
AMSBIO has launched a new 2024 travel grant award scheme for scientists under the age of thirty, employed in academia, research institutions, or companies engaged in cancer and stem cell research. Working closely with the global life science community for over three decades AMSBIO believes in partnership and paying back by supporting new research and researchers. Last year, the company funded a travel grant to attend ISSCR 2023... AMSBIO has expanded its range of high-performance magnetic beads for use as detection labels in magnetic immunoassays or as a solid support phase in immunoassays. MagSi-STA beads are magnetic silica particles with high quality streptavidin covalently attached to the bead surface. Available in different mean sizes, streptavidin coupling chemistries and binding capacities, these industry-leading MagSi-STA beads offer an optimized solution for many in vitro diagnostic applications, including immunoassays.
AMSBIO has expanded its range of high-performance magnetic beads for use as detection labels in magnetic immunoassays or as a solid support phase in immunoassays. MagSi-STA beads are magnetic silica particles with high quality streptavidin covalently attached to the bead surface. Available in different mean sizes, streptavidin coupling chemistries and binding capacities, these industry-leading MagSi-STA beads offer an optimized solution for many in vitro diagnostic applications, including immunoassays. In an informative new blog post - AMSBIO reflects on a selection of the ground breaking life science and biomedical research undertaken by its customers during 2023. From deciphering the intricacies of cancer progression mechanisms to revolutionising wound care, AMSBIO is delighted to have played a supporting role in these scientific endeavours. Discover an exciting collaboration led by Dr. Ashley M. Laughney from Weill Cornell Medicine and Dr. Samuel F. Bakhoum from Memorial Sloan Kettering Cancer Center...
In an informative new blog post - AMSBIO reflects on a selection of the ground breaking life science and biomedical research undertaken by its customers during 2023. From deciphering the intricacies of cancer progression mechanisms to revolutionising wound care, AMSBIO is delighted to have played a supporting role in these scientific endeavours. Discover an exciting collaboration led by Dr. Ashley M. Laughney from Weill Cornell Medicine and Dr. Samuel F. Bakhoum from Memorial Sloan Kettering Cancer Center... The new ABLE 3D Magnetic Stir and Disposable Bioreactor System from AMSBIO provides cost-effective, lab-scale production of induced pluripotent stem (iPS) cell spheroid culture. Induced pluripotent stem cells grown in 3D spheroid suspension culture closely resemble embryoid body structures naturally formed by embryonic stem cells. Using an ABLE 3D Bioreactor offers researchers an easy-to-use and affordable tool that provides excellent yield, viability, and high efficiency for the expansion of human iPS stem cells and differentiation...
The new ABLE 3D Magnetic Stir and Disposable Bioreactor System from AMSBIO provides cost-effective, lab-scale production of induced pluripotent stem (iPS) cell spheroid culture. Induced pluripotent stem cells grown in 3D spheroid suspension culture closely resemble embryoid body structures naturally formed by embryonic stem cells. Using an ABLE 3D Bioreactor offers researchers an easy-to-use and affordable tool that provides excellent yield, viability, and high efficiency for the expansion of human iPS stem cells and differentiation... AMSBIO has published a case study that describes how a team of scientists, led by Dr. Roger Kamm from the Massachusetts Institute of Technology (MIT), has developed a protocol for the fabrication of a 3D microfluidic neuromuscular platform that can be used to model Motor Neuron Diseases (MND’s). Researchers at MIT have developed novel approaches to unravel the pathogenesis of MNDs using CELLBANKER® 1 and STEM-CELLBANKER® cryopreservation media from AMSBIO...
AMSBIO has published a case study that describes how a team of scientists, led by Dr. Roger Kamm from the Massachusetts Institute of Technology (MIT), has developed a protocol for the fabrication of a 3D microfluidic neuromuscular platform that can be used to model Motor Neuron Diseases (MND’s). Researchers at MIT have developed novel approaches to unravel the pathogenesis of MNDs using CELLBANKER® 1 and STEM-CELLBANKER® cryopreservation media from AMSBIO... AMSBIO, a provider of cutting-edge products and services for accelerating stem cell research, has sponsored two aspiring life scientists to attend and present posters at the recent ISSCR 2023 conference in Boston, USA. Whilst the original award was for one researcher, AMSBIO doubled the fund and awarded two grants based on the high quality of the entries. Krystyna Joyce, AMSBIO’s marketing manager, said "The entries were so impressive that we ended up sponsoring two winners instead of one"...
AMSBIO, a provider of cutting-edge products and services for accelerating stem cell research, has sponsored two aspiring life scientists to attend and present posters at the recent ISSCR 2023 conference in Boston, USA. Whilst the original award was for one researcher, AMSBIO doubled the fund and awarded two grants based on the high quality of the entries. Krystyna Joyce, AMSBIO’s marketing manager, said "The entries were so impressive that we ended up sponsoring two winners instead of one"... AMSBIO, a leading supplier of human cell lines and research tools, is proud to announce its collaboration with WARR Space Labs, a student group from the Technical University of Munich (TUM). The students undertook an exciting project aimed at advancing our understanding of neurodegenerative disorders, particularly Alzheimer’s disease, through spaceborne experiments.
AMSBIO, a leading supplier of human cell lines and research tools, is proud to announce its collaboration with WARR Space Labs, a student group from the Technical University of Munich (TUM). The students undertook an exciting project aimed at advancing our understanding of neurodegenerative disorders, particularly Alzheimer’s disease, through spaceborne experiments. AMSBIO announce a new range of pre-made Nano-Lantern lentivirus products that utilize a proprietary lentiviral vector system to enable highly sensitive and precise in vivo luminescence imaging. This cutting-edge Nano-Lantern lentivirus technology, which consists of an enhanced Renilla-Luciferase connected to an Orange Fluorescent protein (OFP), represents a significant improvement over previous methods and is poised to revolutionize many in vivo imaging applications...
AMSBIO announce a new range of pre-made Nano-Lantern lentivirus products that utilize a proprietary lentiviral vector system to enable highly sensitive and precise in vivo luminescence imaging. This cutting-edge Nano-Lantern lentivirus technology, which consists of an enhanced Renilla-Luciferase connected to an Orange Fluorescent protein (OFP), represents a significant improvement over previous methods and is poised to revolutionize many in vivo imaging applications... AMSBIO has published a blog about Dr. Satoshi Okamoto’s groundbreaking research on the production of induced pluripotent stem cells (iPSC)-derived liver organoids, and their significant potential in clinical research trials. The primary objective of Dr. Okamoto's research program at the Yokohama City University Graduate School's Department of Regenerative Medicine was to achieve large-scale, stable production of clinical-grade liver organoids...
AMSBIO has published a blog about Dr. Satoshi Okamoto’s groundbreaking research on the production of induced pluripotent stem cells (iPSC)-derived liver organoids, and their significant potential in clinical research trials. The primary objective of Dr. Okamoto's research program at the Yokohama City University Graduate School's Department of Regenerative Medicine was to achieve large-scale, stable production of clinical-grade liver organoids... AMSBIO announce MatriMix – a groundbreaking 3D culture substrate. This pioneering hydrogel sets a new benchmark in the field, containing fully defined components, including medical grade collagens, laminin-511 E8 fragments, and hyaluronic acid. The high lot-to-lot consistency of MatriMix enables researchers to obtain highly reproducible results. MatriMix overcomes the limitations of current 3D substrates, enabling cutting-edge applications...
AMSBIO announce MatriMix – a groundbreaking 3D culture substrate. This pioneering hydrogel sets a new benchmark in the field, containing fully defined components, including medical grade collagens, laminin-511 E8 fragments, and hyaluronic acid. The high lot-to-lot consistency of MatriMix enables researchers to obtain highly reproducible results. MatriMix overcomes the limitations of current 3D substrates, enabling cutting-edge applications... A recent blog post from AMSBIO introduces a selection of the ‘green products’ it offers to life science researchers looking to maintain rigorous scientific standards in their lab whilst also trying to minimize environmental impact. Laboratories are known to consume a significant amount of energy and produce a considerable amount of waste. However, with the increasing awareness of the importance of sustainability, many life sciences labs are taking steps towards prioritizing sustainable products and practices...
A recent blog post from AMSBIO introduces a selection of the ‘green products’ it offers to life science researchers looking to maintain rigorous scientific standards in their lab whilst also trying to minimize environmental impact. Laboratories are known to consume a significant amount of energy and produce a considerable amount of waste. However, with the increasing awareness of the importance of sustainability, many life sciences labs are taking steps towards prioritizing sustainable products and practices... AMSBIO is pleased to announce the launch of Extragel, a like-for-like replacement for MatrigelTM, GeltrexTM and CultrexTM Basement Membrane Extract (BME). Available ex-stock, with overnight shipment, Extragel is a reconstituted matrix hydrogel formed by basement membrane components extracted from mouse tumor tissues which are rich in extracellular matrix proteins. Designed to be used undiluted or diluted to a specific protein concentration...
AMSBIO is pleased to announce the launch of Extragel, a like-for-like replacement for MatrigelTM, GeltrexTM and CultrexTM Basement Membrane Extract (BME). Available ex-stock, with overnight shipment, Extragel is a reconstituted matrix hydrogel formed by basement membrane components extracted from mouse tumor tissues which are rich in extracellular matrix proteins. Designed to be used undiluted or diluted to a specific protein concentration... AMSBIO has interviewed two extraordinary women in the 3D Cell Culture and Organoid field; Dr Hynda Kleinman, one of the co-inventors of Matrigel, and Dr Meritxell Huch, a director at the Max Planck Institute of Molecular Cell Biology and Genetics (MPI-CBG) to mark International Women’s Day on the 8th March, and World Organoid Research Day on 22nd March 2023...
AMSBIO has interviewed two extraordinary women in the 3D Cell Culture and Organoid field; Dr Hynda Kleinman, one of the co-inventors of Matrigel, and Dr Meritxell Huch, a director at the Max Planck Institute of Molecular Cell Biology and Genetics (MPI-CBG) to mark International Women’s Day on the 8th March, and World Organoid Research Day on 22nd March 2023... The new MagSi-DNA FFPE kit from AMSBIO enables quick and easy isolation of genomic DNA (gDNA) from mammalian formalin-fixed paraffin-embedded (FFPE) tissue or cell samples. Developed using proprietary magnetic bead technology – the MagSi-DNA FFPE kit can be used for manual and automated isolation of gDNA from mammalian FFPE tissue or cell samples...
The new MagSi-DNA FFPE kit from AMSBIO enables quick and easy isolation of genomic DNA (gDNA) from mammalian formalin-fixed paraffin-embedded (FFPE) tissue or cell samples. Developed using proprietary magnetic bead technology – the MagSi-DNA FFPE kit can be used for manual and automated isolation of gDNA from mammalian FFPE tissue or cell samples... AMSBIO reports how the Faculty of Biological Sciences at the University of Leeds (UK) is using their specialty reagents for the production, visualization, and analysis of glycans and to investigate their interactions which are instrumental to the advance of glycobiology. Glycobiology is vital for many biological processes — from fertilization to inflammation — helping unlock information about interactions between carbohydrates and proteins...
AMSBIO reports how the Faculty of Biological Sciences at the University of Leeds (UK) is using their specialty reagents for the production, visualization, and analysis of glycans and to investigate their interactions which are instrumental to the advance of glycobiology. Glycobiology is vital for many biological processes — from fertilization to inflammation — helping unlock information about interactions between carbohydrates and proteins... AMSBIO announce a new range of different isolation products for fast, scalable, and reproducible purification of Extracellular Vesicles (EV), including exosomes, as well as addressing EV heterogeneity and high throughput solutions for biomarker discovery. Traditionally ultracentrifugation has been the favored method for EV isolation or separation. Though it is still widely used, ultracentrifugation not only tends to alter the vesicle shape and functionality but is time-consuming and requires expensive equipment...
AMSBIO announce a new range of different isolation products for fast, scalable, and reproducible purification of Extracellular Vesicles (EV), including exosomes, as well as addressing EV heterogeneity and high throughput solutions for biomarker discovery. Traditionally ultracentrifugation has been the favored method for EV isolation or separation. Though it is still widely used, ultracentrifugation not only tends to alter the vesicle shape and functionality but is time-consuming and requires expensive equipment... AMSBIO offers a wide range of small molecules to provide scientists with targeted tools to direct cell fates, making them crucial in areas including regenerative medicine and cancer research. Small molecules are cell-permeable organic compounds with low molecular weights, which are chemically produced, in contrast to larger molecules such as proteins which are often produced via biological means...
AMSBIO offers a wide range of small molecules to provide scientists with targeted tools to direct cell fates, making them crucial in areas including regenerative medicine and cancer research. Small molecules are cell-permeable organic compounds with low molecular weights, which are chemically produced, in contrast to larger molecules such as proteins which are often produced via biological means... AMSBIO has published an informative handbook for scientists who need to preserve or archive organoids in a research lab. The handbook brings together published paper citations, quotes and data from leading international research groups who are using the CELLBANKER® range of products to cryopreserve their organoids simply and safely. In addition, the handbook includes best practice protocols plus information making it easier to understand the process of freezing organoids...
AMSBIO has published an informative handbook for scientists who need to preserve or archive organoids in a research lab. The handbook brings together published paper citations, quotes and data from leading international research groups who are using the CELLBANKER® range of products to cryopreserve their organoids simply and safely. In addition, the handbook includes best practice protocols plus information making it easier to understand the process of freezing organoids... AMSBIO has added a new range of Vesicular Stomatitis Virus (VSV) to its suite of virus-based tools for cell engineering and the study of viral infection. Vesicular Stomatitis Virus is an enveloped, negative-stranded RNA virus with a simple structure. Its ability to infect a wide range of mammalian cell types has made it a valuable tool to study virus entry, replication, and assembly. A key advantage of the AMSBIO VSV model is that it undergoes only one round of replication....
AMSBIO has added a new range of Vesicular Stomatitis Virus (VSV) to its suite of virus-based tools for cell engineering and the study of viral infection. Vesicular Stomatitis Virus is an enveloped, negative-stranded RNA virus with a simple structure. Its ability to infect a wide range of mammalian cell types has made it a valuable tool to study virus entry, replication, and assembly. A key advantage of the AMSBIO VSV model is that it undergoes only one round of replication.... AMSBIO announce RNAdvantage – the first product in a new range of stabilization solutions that provide robust protection for your RNA samples at ambient temperature. Designed to protect and preserve RNA from most tissues, cultured cells, bacteria, and yeast for up to 14-days, RNAdvantage eliminates the traditional costs of flash freezing samples dry-ice shipping and freezer storage...
AMSBIO announce RNAdvantage – the first product in a new range of stabilization solutions that provide robust protection for your RNA samples at ambient temperature. Designed to protect and preserve RNA from most tissues, cultured cells, bacteria, and yeast for up to 14-days, RNAdvantage eliminates the traditional costs of flash freezing samples dry-ice shipping and freezer storage... AMSBIO has published an interview with Professor Marius Wernig from Stanford University, Pathology Stem Cell Institute that discusses what could be the world’s first widely applicable curative treatment for Epidermolysis Bullosa (EB). This rare genetic disease causes chronic and incredibly painful skin wounds that often lead to an aggressive form of skin cancer and eventual death...
AMSBIO has published an interview with Professor Marius Wernig from Stanford University, Pathology Stem Cell Institute that discusses what could be the world’s first widely applicable curative treatment for Epidermolysis Bullosa (EB). This rare genetic disease causes chronic and incredibly painful skin wounds that often lead to an aggressive form of skin cancer and eventual death... Lentiviral vectors are a valuable tool for delivering target genes into most types of dividing and non-dividing mammalian cells in vitro and in vivo. Typically, production of custom lentiviral vectors is a laborious and challenging process, especially when high-titer lentiviral vectors are required. The custom lentiviral vector production service from AMSBO offers researchers a proven partner to avoid this bottleneck and speed up your research...
Lentiviral vectors are a valuable tool for delivering target genes into most types of dividing and non-dividing mammalian cells in vitro and in vivo. Typically, production of custom lentiviral vectors is a laborious and challenging process, especially when high-titer lentiviral vectors are required. The custom lentiviral vector production service from AMSBO offers researchers a proven partner to avoid this bottleneck and speed up your research... A screening tool developed in research led at the University of Strathclyde, UK could increase the number of tests on a solid tumour sample by up to 50 times. The tool is designed for testing at scale the latest immunotherapies, such as Chimeric Antigen Receptor (CAR) T-cell therapy, which is effective against many haematological cancers but presents challenges when used to treat solid tumours. Traditional 2D models that are currently used fail to reproduce the complexity of the tumour’s microenvironment...
A screening tool developed in research led at the University of Strathclyde, UK could increase the number of tests on a solid tumour sample by up to 50 times. The tool is designed for testing at scale the latest immunotherapies, such as Chimeric Antigen Receptor (CAR) T-cell therapy, which is effective against many haematological cancers but presents challenges when used to treat solid tumours. Traditional 2D models that are currently used fail to reproduce the complexity of the tumour’s microenvironment... AMSBIO announce a new range of high-quality bispecific antibodies (BsAbs) and trispecific antibodies (TsAbs) that can used to provide enhanced cancer therapeutic efficacy and/or safety compared to what can be achieved with conventional monospecific antibodies. The concept of using a molecule with more than one binding site to enhance its biological function has been around for some time....
AMSBIO announce a new range of high-quality bispecific antibodies (BsAbs) and trispecific antibodies (TsAbs) that can used to provide enhanced cancer therapeutic efficacy and/or safety compared to what can be achieved with conventional monospecific antibodies. The concept of using a molecule with more than one binding site to enhance its biological function has been around for some time.... AMSBIO announces the launch of the QuicKey Pro™ range of ELISA kits – new easy-to-use assays that require just one step of washing, and one step of sample addition, resulting in a whole experiment taking only 90 minutes. Compared with traditional ELISA kits, the total procedure time using a QuicKey Pro™ ELISA kit is reduced by 1-2 hours, resulting in significant gains in experimental efficiency....
AMSBIO announces the launch of the QuicKey Pro™ range of ELISA kits – new easy-to-use assays that require just one step of washing, and one step of sample addition, resulting in a whole experiment taking only 90 minutes. Compared with traditional ELISA kits, the total procedure time using a QuicKey Pro™ ELISA kit is reduced by 1-2 hours, resulting in significant gains in experimental efficiency.... AMSBIO has introduced further essential tools for SARS-CoV-2 researchers to help decipher the COVID-19 B.1.1.529 variant. New to the AMSBIO range are recombinant proteins, easy-to-perform assay kits, Omicron pseudotyped lentiviruses and spike neutralizing antibodies for use in functional assays to block SARS-CoV-2 spike protein and ACE2 binding...
AMSBIO has introduced further essential tools for SARS-CoV-2 researchers to help decipher the COVID-19 B.1.1.529 variant. New to the AMSBIO range are recombinant proteins, easy-to-perform assay kits, Omicron pseudotyped lentiviruses and spike neutralizing antibodies for use in functional assays to block SARS-CoV-2 spike protein and ACE2 binding... AMSBIO announce the addition of several new products to its growing range of magnetic bead based nucleic acid extraction kits for pathogens detection. The MagSi-NA Pathogens MSP (Multiple Sample Pooling) kit sets a new benchmark for automated isolation of nucleic acids (RNA and DNA) from respiratory samples. Sample pooling is useful in times of high testing and low infection prevalence where traditional sample screening methods are not cost-effective....
AMSBIO announce the addition of several new products to its growing range of magnetic bead based nucleic acid extraction kits for pathogens detection. The MagSi-NA Pathogens MSP (Multiple Sample Pooling) kit sets a new benchmark for automated isolation of nucleic acids (RNA and DNA) from respiratory samples. Sample pooling is useful in times of high testing and low infection prevalence where traditional sample screening methods are not cost-effective.... AMSBIO has announced new additions to its portfolio of tools for COVID-19 research - two monoclonal antibodies that recognize the Spike RBD (B.1.1.529, Omicron Variant) protein and neutralizes its interaction with ACE2. The human ACE2 receptor is found on the surface of type I and II pneumocytes, endothelial cells, and ciliated bronchial epithelial cells. Research has shown that ACE2 mediates COVID-19 infection through direct binding of the SARS-CoV-2 Spike protein....
AMSBIO has announced new additions to its portfolio of tools for COVID-19 research - two monoclonal antibodies that recognize the Spike RBD (B.1.1.529, Omicron Variant) protein and neutralizes its interaction with ACE2. The human ACE2 receptor is found on the surface of type I and II pneumocytes, endothelial cells, and ciliated bronchial epithelial cells. Research has shown that ACE2 mediates COVID-19 infection through direct binding of the SARS-CoV-2 Spike protein.... AMSBIO has announced a new range of kits, media and reagents to assist in the development of cultured meat products - an exciting new area of food technology. Cultured meat, also known as synthetic, artificial or in-vitro meat, is created by harvesting animal cells that are then placed in a bioreactor and fed with nutrients to help tissue growth. The driving force behind this rapidly expanding area of food technology is that the production of cultured meat requires far fewer animals to be farmed...
AMSBIO has announced a new range of kits, media and reagents to assist in the development of cultured meat products - an exciting new area of food technology. Cultured meat, also known as synthetic, artificial or in-vitro meat, is created by harvesting animal cells that are then placed in a bioreactor and fed with nutrients to help tissue growth. The driving force behind this rapidly expanding area of food technology is that the production of cultured meat requires far fewer animals to be farmed... Global provider of human and animal biospecimens - AMSBIO offers a custom procurement service enabling researchers to source specific biofluid and tissue samples which are not already available in their extensive biorepository. To support increasingly complex research, AMSBIO aims to provide a full range of blood-based products, including whole blood, serum, plasma, blood and peripheral blood mononuclear cells (PBMCs)....
Global provider of human and animal biospecimens - AMSBIO offers a custom procurement service enabling researchers to source specific biofluid and tissue samples which are not already available in their extensive biorepository. To support increasingly complex research, AMSBIO aims to provide a full range of blood-based products, including whole blood, serum, plasma, blood and peripheral blood mononuclear cells (PBMCs).... AMSBIO has launched a new range of research grade biosimilars that enable analysis of biological processes without the need to purchase expensive therapeutic-grade biologics. Investigating the biological effects of a drug or doing proof of concept assay development, requires a source of the drug. Typically, it is difficult to obtain original pharmaceutical grade biotherapeutic drugs for research use, rather than a clinical application....
AMSBIO has launched a new range of research grade biosimilars that enable analysis of biological processes without the need to purchase expensive therapeutic-grade biologics. Investigating the biological effects of a drug or doing proof of concept assay development, requires a source of the drug. Typically, it is difficult to obtain original pharmaceutical grade biotherapeutic drugs for research use, rather than a clinical application.... AMSBIO has established an unmatched commercial biorepository and procurement network that includes a large selection of fully characterized and annotated Formalin-Fixed Paraffin-Embedded (FFPE) tissue blocks to help streamline your research. Drawing upon decades of experience - AMSBIO is able to offer an extensive collection of frozen and paraffin-embedded (FFPE) human and animal tissue samples from normal and many diseased tissue types....
AMSBIO has established an unmatched commercial biorepository and procurement network that includes a large selection of fully characterized and annotated Formalin-Fixed Paraffin-Embedded (FFPE) tissue blocks to help streamline your research. Drawing upon decades of experience - AMSBIO is able to offer an extensive collection of frozen and paraffin-embedded (FFPE) human and animal tissue samples from normal and many diseased tissue types.... AMSBIO invite the global research community to the 2021 annual meeting of the ISSCR, the leading professional organization of stem cell scientists, to discover how iPSCs and organoids can be used in COVID-19 drug discovery research. At this virtual meeting - Dr. Kazuo Takayama from the renowned Center for iPS Cell Research and application (CiRA) at Kyoto University will be giving a unique insight into his recent pioneering research...
AMSBIO invite the global research community to the 2021 annual meeting of the ISSCR, the leading professional organization of stem cell scientists, to discover how iPSCs and organoids can be used in COVID-19 drug discovery research. At this virtual meeting - Dr. Kazuo Takayama from the renowned Center for iPS Cell Research and application (CiRA) at Kyoto University will be giving a unique insight into his recent pioneering research... AMSBIO reports upon a publication that cites how its STEM-CELLBANKER® animal-free cryopreservation media has played a role in the development of a cell therapy for Parkinson’s Disease that will soon be going into clinical trials. Parkinson’s disease is one of the most common neurodegenerative diseases worldwide. Its main features include motor symptoms such as bradykinesia, rigidity, resting tremor, and postural instability, though non-motor symptoms are often also present....
AMSBIO reports upon a publication that cites how its STEM-CELLBANKER® animal-free cryopreservation media has played a role in the development of a cell therapy for Parkinson’s Disease that will soon be going into clinical trials. Parkinson’s disease is one of the most common neurodegenerative diseases worldwide. Its main features include motor symptoms such as bradykinesia, rigidity, resting tremor, and postural instability, though non-motor symptoms are often also present.... AMSBIO has launched two new biotinylated formats of the 10E4 Heparan Sulfate antibody (high and low biotin) along with a starter pack to allow scientists to test both formats at a reduced cost. Heparan Sulfate (HS) is a highly sulfated linear polysaccharide that is attached to a core protein to form HS Proteoglycans on the cell membrane or in the extracellular matrix....
AMSBIO has launched two new biotinylated formats of the 10E4 Heparan Sulfate antibody (high and low biotin) along with a starter pack to allow scientists to test both formats at a reduced cost. Heparan Sulfate (HS) is a highly sulfated linear polysaccharide that is attached to a core protein to form HS Proteoglycans on the cell membrane or in the extracellular matrix.... AMSBIO has introduced a collection of mutated SARS-CoV-2 spike proteins and recombinant antigens for the new virus variants - B.1.1.7 and B.1.351. These reagents can be used by researchers to evaluate the efficacy of the antibodies and identify targets for development of improved therapeutic drugs and vaccines. Emerging in the latter part of 2020, multiple new SARS-CoV-2 variants are now circulating globally....
AMSBIO has introduced a collection of mutated SARS-CoV-2 spike proteins and recombinant antigens for the new virus variants - B.1.1.7 and B.1.351. These reagents can be used by researchers to evaluate the efficacy of the antibodies and identify targets for development of improved therapeutic drugs and vaccines. Emerging in the latter part of 2020, multiple new SARS-CoV-2 variants are now circulating globally.... AMSBIO has introduced a series of kit products based upon high-quality SARS-CoV-2 antigen proteins to improve the efficiency of anti-SARS-CoV-2 drugs and vaccines development. These new kit products include SARS-CoV-2 inhibitor screening kits, antibody titer serologic assay kits, antigen detection kit and antigen pre-coated plates....
AMSBIO has introduced a series of kit products based upon high-quality SARS-CoV-2 antigen proteins to improve the efficiency of anti-SARS-CoV-2 drugs and vaccines development. These new kit products include SARS-CoV-2 inhibitor screening kits, antibody titer serologic assay kits, antigen detection kit and antigen pre-coated plates.... AMSBIO has published an interview with researchers at Yamaguchi University Graduate School of Medicine, Department of Gastroenterology and Hepatology, Japan, that covers their groundbreaking work to develop cell regeneration therapies for liver cirrhosis. The interview covers the involvement of the Graduate School of Medicine in the development of StemFit® for Mesenchymal Stem Cell (MSC), a new chemically defined medium which minimizes the risk of hazardous animal derived ingredients....
AMSBIO has published an interview with researchers at Yamaguchi University Graduate School of Medicine, Department of Gastroenterology and Hepatology, Japan, that covers their groundbreaking work to develop cell regeneration therapies for liver cirrhosis. The interview covers the involvement of the Graduate School of Medicine in the development of StemFit® for Mesenchymal Stem Cell (MSC), a new chemically defined medium which minimizes the risk of hazardous animal derived ingredients.... Using HS antibodies from AMSBIO, researchers have demonstrated that Heparanase enzyme contributes to the pathogenesis of COVID-19, with both Heparanase activity and HS levels being elevated in plasma of Covid-19 patients. In addition, recent published data has shown that Heparanase activity is further elevated in ICU patients on ventilators compared to less serious cases....
Using HS antibodies from AMSBIO, researchers have demonstrated that Heparanase enzyme contributes to the pathogenesis of COVID-19, with both Heparanase activity and HS levels being elevated in plasma of Covid-19 patients. In addition, recent published data has shown that Heparanase activity is further elevated in ICU patients on ventilators compared to less serious cases.... AMSBIO has further expanded its product range to help in the fight against COVID-19 with the introduction of a new range of SARS-CoV-2 antibodies and antigens to aid development of new immunoassay diagnostic kits. While RT-PCR diagnostic kits has provided fast and sensitive COVID-19 case confirmation, the technique suffers from some inherent drawbacks that limit it to diagnosis during the acute phase of infection....
AMSBIO has further expanded its product range to help in the fight against COVID-19 with the introduction of a new range of SARS-CoV-2 antibodies and antigens to aid development of new immunoassay diagnostic kits. While RT-PCR diagnostic kits has provided fast and sensitive COVID-19 case confirmation, the technique suffers from some inherent drawbacks that limit it to diagnosis during the acute phase of infection.... AMSBIO announce new additions and certifications for their market-leading range of clinical grade, chemically defined cryopreservation excipient solutions - STEM-CELLBANKER® and HSC-BANKER®. STEM-CELLBANKER® DMSO Free GMP grade is a new chemically defined freezing solution that does not contain DMSO as an anti-freezing agent. It was developed for customers who prefer not to use DMSO-containing cryopreservation solution...
AMSBIO announce new additions and certifications for their market-leading range of clinical grade, chemically defined cryopreservation excipient solutions - STEM-CELLBANKER® and HSC-BANKER®. STEM-CELLBANKER® DMSO Free GMP grade is a new chemically defined freezing solution that does not contain DMSO as an anti-freezing agent. It was developed for customers who prefer not to use DMSO-containing cryopreservation solution... AMSBIO announce a new service designed to provide high-content cytometry data on cells and tissues enabling the automated analysis of fluorescent biomarkers on living cells or long-term stored biobanked cells and tissues. Leveraging the innovative ChipCytometry platform, AMSBIO is able to offer a complete workflow solution (products and services) for high-content cytometry on cells and tissues, from sample preparation and biobanking to biomarker analysis and data mining....
AMSBIO announce a new service designed to provide high-content cytometry data on cells and tissues enabling the automated analysis of fluorescent biomarkers on living cells or long-term stored biobanked cells and tissues. Leveraging the innovative ChipCytometry platform, AMSBIO is able to offer a complete workflow solution (products and services) for high-content cytometry on cells and tissues, from sample preparation and biobanking to biomarker analysis and data mining.... Exosomes are small endosome derived lipid nanoparticles, actively secreted by exocytosis in most living cells. Acting on tissues in both the local environment and further afield, they function as important signal carriers through their transport of RNA, proteins, lipids and DNA. Exosomes are involved in a wide range of normal and pathogenic processes, making exosome research crucial in multiple areas....
Exosomes are small endosome derived lipid nanoparticles, actively secreted by exocytosis in most living cells. Acting on tissues in both the local environment and further afield, they function as important signal carriers through their transport of RNA, proteins, lipids and DNA. Exosomes are involved in a wide range of normal and pathogenic processes, making exosome research crucial in multiple areas.... AMSBIO has launched a range of ready-to-use SARS-CoV-2 Spike protein coupled magnetic beads that combine convenience, minimum non-specific binding and developed operational protocols saving you time and hassle. Developed for immunocapture, cell stimulating, biopanning and flow cytometry applications these new products use biotinylated SARS-CoV-2 Spike protein pre-coupled to streptavidin conjugated magnetic beads, which can capture the Anti-SARS-CoV-2 antibody or ACE2 protein from cell or serum sample....
AMSBIO has launched a range of ready-to-use SARS-CoV-2 Spike protein coupled magnetic beads that combine convenience, minimum non-specific binding and developed operational protocols saving you time and hassle. Developed for immunocapture, cell stimulating, biopanning and flow cytometry applications these new products use biotinylated SARS-CoV-2 Spike protein pre-coupled to streptavidin conjugated magnetic beads, which can capture the Anti-SARS-CoV-2 antibody or ACE2 protein from cell or serum sample.... AMSBIO reports on the pioneering work by researchers at the University of Sheffield, UK to measure the interaction between the SARS-CoV-2 Spike S1 protein receptor binding domain (SARS-CoV-2 S1 RBD) and heparin. This has resulted in a new assay which could be a useful first screen for novel inhibitors of coronavirus infection. Evidence is mounting that SARS-CoV-2 uses heparan sulfates (HS) during the initial attachment to hosts cells, and this interaction appears to increase the affinity for the critical receptor, ACE2....
AMSBIO reports on the pioneering work by researchers at the University of Sheffield, UK to measure the interaction between the SARS-CoV-2 Spike S1 protein receptor binding domain (SARS-CoV-2 S1 RBD) and heparin. This has resulted in a new assay which could be a useful first screen for novel inhibitors of coronavirus infection. Evidence is mounting that SARS-CoV-2 uses heparan sulfates (HS) during the initial attachment to hosts cells, and this interaction appears to increase the affinity for the critical receptor, ACE2.... The MagSi-NA Pathogens Kit from AMSBIO enables easy extraction of DNA and RNA from serum, plasma, oropharyngeal swab / nasopharyngeal swab, and any other respiratory samples for pathogen detection. The kit is particularly suitable for total nucleic acid extraction for SARS-CoV-2 / COVID-19 detection, currently a major bottleneck in COVID-19 testing....
The MagSi-NA Pathogens Kit from AMSBIO enables easy extraction of DNA and RNA from serum, plasma, oropharyngeal swab / nasopharyngeal swab, and any other respiratory samples for pathogen detection. The kit is particularly suitable for total nucleic acid extraction for SARS-CoV-2 / COVID-19 detection, currently a major bottleneck in COVID-19 testing.... AMSBIO announce the availability of recombinant proteins and antibodies for detection of Coronavirus (COVID-19) and related RNA viruses. Historically strains of Coronavirus able to infect humans (HCoV-OC43, HCoV-229E, HCoV-NL63, and HCoVHKU1) were not highly pathogenic and only caused mild respiratory illness. By comparison more recent strains - SARS-CoV, MERS-CoV and COVID-19 that emerged in Wuhan, China at the end of 2019 are highly pathogenic resulting in large scale pandemics....
AMSBIO announce the availability of recombinant proteins and antibodies for detection of Coronavirus (COVID-19) and related RNA viruses. Historically strains of Coronavirus able to infect humans (HCoV-OC43, HCoV-229E, HCoV-NL63, and HCoVHKU1) were not highly pathogenic and only caused mild respiratory illness. By comparison more recent strains - SARS-CoV, MERS-CoV and COVID-19 that emerged in Wuhan, China at the end of 2019 are highly pathogenic resulting in large scale pandemics.... The EZ PREP Peripheral Blood Mononuclear Cell Isolation Kit from AMSBIO is designed to efficiently isolate highly purified peripheral blood mononuclear cells (PBMCs) from fresh whole blood products by density gradient centrifugation. The unique EZ PREP tube design provides greater visibility of your target cell population, allowing you to maximise your recovery of mononuclear cells. As a result, PBMCs are immediately available for downstream applications such as flow cytometry, culture, and/or DNA/RNA isolation...
The EZ PREP Peripheral Blood Mononuclear Cell Isolation Kit from AMSBIO is designed to efficiently isolate highly purified peripheral blood mononuclear cells (PBMCs) from fresh whole blood products by density gradient centrifugation. The unique EZ PREP tube design provides greater visibility of your target cell population, allowing you to maximise your recovery of mononuclear cells. As a result, PBMCs are immediately available for downstream applications such as flow cytometry, culture, and/or DNA/RNA isolation... ScreenIn3D, a partner of AMSBIO, has been awarded the prestigious ELRIG Prize for Innovation in Drug Discovery at their flagship conference Drug Discovery 2019 which recently took place in Liverpool, UK. ELRIG Drug Discovery has become the largest meeting of life sciences industry professionals in the UK. The 2-day event brings together more than 1200 delegates and over 100 exhibiting companies from around the world to highlight the latest ground-breaking research....
ScreenIn3D, a partner of AMSBIO, has been awarded the prestigious ELRIG Prize for Innovation in Drug Discovery at their flagship conference Drug Discovery 2019 which recently took place in Liverpool, UK. ELRIG Drug Discovery has become the largest meeting of life sciences industry professionals in the UK. The 2-day event brings together more than 1200 delegates and over 100 exhibiting companies from around the world to highlight the latest ground-breaking research.... AMSBIO reports on a paper from the Malmberg Lab at Oslo University Hospital and the Norwegian Radium Hospital Institute for Cancer Research (Norway) that suggests a mechanism by which Natural Killer (NK) cell education operates through modulation of the lysosomal compartment under the influence of inhibitory receptor–ligand interactions....
AMSBIO reports on a paper from the Malmberg Lab at Oslo University Hospital and the Norwegian Radium Hospital Institute for Cancer Research (Norway) that suggests a mechanism by which Natural Killer (NK) cell education operates through modulation of the lysosomal compartment under the influence of inhibitory receptor–ligand interactions.... AMSBIO has introduced a new range of homogeneous proximity assays, critical enzymes and small molecule inhibitors to assess the chemical adaptor function of Proteolysis Targeting Chimeras (PROTACs). Targeted protein degradation using PROTACs is a new and promising therapeutic method in drug discovery....
AMSBIO has introduced a new range of homogeneous proximity assays, critical enzymes and small molecule inhibitors to assess the chemical adaptor function of Proteolysis Targeting Chimeras (PROTACs). Targeted protein degradation using PROTACs is a new and promising therapeutic method in drug discovery.... AMSBIO announce new, best-in-class CAR-T cells, engineered CAR-T target cells, PBMC, cell media and activation beads in response to the rapid growth in research on the therapeutic uses of CAR-T cells. All CAR-T cell products from AMSBIO are T cells produced from either a group of donors or from individual donor transduced with CAR (Chimeric antigen receptor) - lentivirus....
AMSBIO announce new, best-in-class CAR-T cells, engineered CAR-T target cells, PBMC, cell media and activation beads in response to the rapid growth in research on the therapeutic uses of CAR-T cells. All CAR-T cell products from AMSBIO are T cells produced from either a group of donors or from individual donor transduced with CAR (Chimeric antigen receptor) - lentivirus.... ScreenIn3D, a partner of AMSBIO, has received a share of the £1 million plus prize pot and will receive ongoing support from partners of Scottish Edge - a respected regional business support agency. Scottish EDGE runs a competition aimed at identifying and supporting Scotland’s up-and-coming, innovative, high-growth potential entrepreneurial talent....
ScreenIn3D, a partner of AMSBIO, has received a share of the £1 million plus prize pot and will receive ongoing support from partners of Scottish Edge - a respected regional business support agency. Scottish EDGE runs a competition aimed at identifying and supporting Scotland’s up-and-coming, innovative, high-growth potential entrepreneurial talent.... AMSBIO reports on the pioneering research published in a collaborative effort between researchers in the School of Engineering, University of Newcastle and Department of Pharmacology, University of Cambridge, UK that has cited Biotinylated Hyaluronan Binding Protein (biotin-HABP) supplied by the company in its investigation into the cancer resistance of the naked mole-rat (NMR)....
AMSBIO reports on the pioneering research published in a collaborative effort between researchers in the School of Engineering, University of Newcastle and Department of Pharmacology, University of Cambridge, UK that has cited Biotinylated Hyaluronan Binding Protein (biotin-HABP) supplied by the company in its investigation into the cancer resistance of the naked mole-rat (NMR).... AMSBIO introduces StemFit® Basic04, a next generation feeder-free medium for the maintenance of Induced Pluripotent Stem (iPS) and Embryonic Stem (ES) cells during the reprogramming, expansion and differentiation phases of stem cell culture. With its fully defined and animal-origin free formulation, StemFit® Basic04 is suited to both research studies and translation to cell therapy. With the new StemFit® Basic04 it is now possible to experience...
AMSBIO introduces StemFit® Basic04, a next generation feeder-free medium for the maintenance of Induced Pluripotent Stem (iPS) and Embryonic Stem (ES) cells during the reprogramming, expansion and differentiation phases of stem cell culture. With its fully defined and animal-origin free formulation, StemFit® Basic04 is suited to both research studies and translation to cell therapy. With the new StemFit® Basic04 it is now possible to experience... AMSBIO announces XerumFree™- a new concept in cell culture that allows you to culture cells without the use of serum. XerumFree™ has been developed taking into account what is missing in traditional basal cell culture media to sustain growth of all cell types, which is a nutritional approach at the cellular level. Containing no animal or human derived material, XerumFree™ is a serum....
AMSBIO announces XerumFree™- a new concept in cell culture that allows you to culture cells without the use of serum. XerumFree™ has been developed taking into account what is missing in traditional basal cell culture media to sustain growth of all cell types, which is a nutritional approach at the cellular level. Containing no animal or human derived material, XerumFree™ is a serum.... AMSBIO reports on how several leading European research groups have used their Lipidure® coated microplates to help culture physiologically functional, light-responsive retinal organoids. Development of in vitro models of the human retina in which to perform pharmacological and toxicological studies is an urgent area of vital research. An essential step for developing in vitro models of human retina is the ability to generate laminated....
AMSBIO reports on how several leading European research groups have used their Lipidure® coated microplates to help culture physiologically functional, light-responsive retinal organoids. Development of in vitro models of the human retina in which to perform pharmacological and toxicological studies is an urgent area of vital research. An essential step for developing in vitro models of human retina is the ability to generate laminated.... AMSBIO offers an unmatched portfolio of over 2000 tissue microarrays (TMAs), one of the best sample formats for rapid detection of cellular localization of RNA and protein expression. Recently AMSBIO introduced US Food & Drug Administration (FDA) standard TMAs for human, mouse and rat to its portfolio. Designed in close conformance with FDA guidelines, this range meets the requirements for tissue cross-reactivity studies required for therapeutic and diagnostic antibody and antibody-like...
AMSBIO offers an unmatched portfolio of over 2000 tissue microarrays (TMAs), one of the best sample formats for rapid detection of cellular localization of RNA and protein expression. Recently AMSBIO introduced US Food & Drug Administration (FDA) standard TMAs for human, mouse and rat to its portfolio. Designed in close conformance with FDA guidelines, this range meets the requirements for tissue cross-reactivity studies required for therapeutic and diagnostic antibody and antibody-like... AMSBIO has added a new range of GCaMP calcium indicators (jGCaMP7b, jGCaMP7c, jGCaMP7f, jGCaMP7s) to their portfolio of ready-to-use adeno-associated virus (AAV) biosensor products. These viruses encoded biosensors are supplied ready for use for neural activity studies in vivo. AAV Biosensors provide a snapshot of intracellular interactions, specifically active brain circuitry. Using fluorescent protein-based AAV...
AMSBIO has added a new range of GCaMP calcium indicators (jGCaMP7b, jGCaMP7c, jGCaMP7f, jGCaMP7s) to their portfolio of ready-to-use adeno-associated virus (AAV) biosensor products. These viruses encoded biosensors are supplied ready for use for neural activity studies in vivo. AAV Biosensors provide a snapshot of intracellular interactions, specifically active brain circuitry. Using fluorescent protein-based AAV... Detachin™ Cell Detachment Solution from AMSBIO is a high-performance alternative to Trypsin/EDTA for detaching adherent cells from in vitro growth vessels. Detachin™ provides rapid, gentle, and effective detachment of a wide variety of adherent cells, including primary cells, from all commercially available tissue culture plasticware. Proven to provide a consistent, safe, and efficient method for cell detachment and dissociation....
Detachin™ Cell Detachment Solution from AMSBIO is a high-performance alternative to Trypsin/EDTA for detaching adherent cells from in vitro growth vessels. Detachin™ provides rapid, gentle, and effective detachment of a wide variety of adherent cells, including primary cells, from all commercially available tissue culture plasticware. Proven to provide a consistent, safe, and efficient method for cell detachment and dissociation.... AMSBIO has established a comprehensive portfolio of knock-out cell lines and lysates generated with CRISPR/Cas9 technology. Using CRISPR/Cas9 gene editing technology for the generation of knock-out cell lines and cell lysates ensures the development of useful tools to validate antibody specificity and elucidate gene function. Knock-out cell lines and cell lysates are widely agreed to be the best negative controls to quickly and confidently...
AMSBIO has established a comprehensive portfolio of knock-out cell lines and lysates generated with CRISPR/Cas9 technology. Using CRISPR/Cas9 gene editing technology for the generation of knock-out cell lines and cell lysates ensures the development of useful tools to validate antibody specificity and elucidate gene function. Knock-out cell lines and cell lysates are widely agreed to be the best negative controls to quickly and confidently... AMSBIO is a leading supplier of gold, silver and platinum coated substrates for nanotechnology researchers looking to use these surfaces to characterize self-assembled monolayers using atomic force microscopy (AFM), or scanning tunneling microscopy (STM). Gold, silver and platinum surfaces offer a clean, near atomically-flat surface that is ideal for applications in nanotechnology, such as studies on self-assembly, single-molecule imaging, nano- or micro-contact printing, DNA origami, or nanophotonics....
AMSBIO is a leading supplier of gold, silver and platinum coated substrates for nanotechnology researchers looking to use these surfaces to characterize self-assembled monolayers using atomic force microscopy (AFM), or scanning tunneling microscopy (STM). Gold, silver and platinum surfaces offer a clean, near atomically-flat surface that is ideal for applications in nanotechnology, such as studies on self-assembly, single-molecule imaging, nano- or micro-contact printing, DNA origami, or nanophotonics.... AMSBIO has added new experimental cell lines to its CAR T cell research range. Recent FDA approval of CAR T cells for treatment of leukemia and lymphoma has resulted in rapid growth in research on the therapeutic uses of such cells. The new AMSBIO experimental cell lines provide you with the power to screen antibodies and ligands against your target, enhancing your search for new CAR T therapies....
AMSBIO has added new experimental cell lines to its CAR T cell research range. Recent FDA approval of CAR T cells for treatment of leukemia and lymphoma has resulted in rapid growth in research on the therapeutic uses of such cells. The new AMSBIO experimental cell lines provide you with the power to screen antibodies and ligands against your target, enhancing your search for new CAR T therapies.... AMSBIO, a leading global supplier of Chondroitinase ABC enzyme, reports on the recent publication by Hu et al. of the therapeutic efficacy of microtube-embedded Chondroitinase ABC on a group of dogs with naturally occurring spinal injuries. Developing new therapies for human spinal cord injuries is a challenging task because the damage is heterogeneous in terms of spinal location and severity. Ideally a new therapy should work for survivors with...
AMSBIO, a leading global supplier of Chondroitinase ABC enzyme, reports on the recent publication by Hu et al. of the therapeutic efficacy of microtube-embedded Chondroitinase ABC on a group of dogs with naturally occurring spinal injuries. Developing new therapies for human spinal cord injuries is a challenging task because the damage is heterogeneous in terms of spinal location and severity. Ideally a new therapy should work for survivors with... AMSBIO has expanded its range of Wingless/Integrated (Wnt) recombinant proteins, stable reporter cell lines, antibodies and ELISA kits to assist researchers in the fields of developmental biology and oncology. The Wnt family of cysteine-rich secreted polypeptides comprise more than 16 mammalian family members involved in several important cell functions such as cell cell-cell communication, proliferation...
AMSBIO has expanded its range of Wingless/Integrated (Wnt) recombinant proteins, stable reporter cell lines, antibodies and ELISA kits to assist researchers in the fields of developmental biology and oncology. The Wnt family of cysteine-rich secreted polypeptides comprise more than 16 mammalian family members involved in several important cell functions such as cell cell-cell communication, proliferation... AMSBIO introduces ALiCE® - a new high yield cell-free protein expression system. Cell-free protein expression (CFPE) is today used by protein chemists to quickly produce small amounts of proteins when screening DNA libraries. However current technologies are limited and there is a need for higher protein expression yields. ALiCE® is a unique eukaryotic system, which yields an unprecedented 3 mg/ml of protein in batch mode...
AMSBIO introduces ALiCE® - a new high yield cell-free protein expression system. Cell-free protein expression (CFPE) is today used by protein chemists to quickly produce small amounts of proteins when screening DNA libraries. However current technologies are limited and there is a need for higher protein expression yields. ALiCE® is a unique eukaryotic system, which yields an unprecedented 3 mg/ml of protein in batch mode... AMSBIO announces that induced pluripotent stem (iPS) cell expert - Dr Masato Nakagawa from the Nobel Prize winning Yamanaka Lab at the Centre for iPS Cell Research and Application, Kyoto University, Japan will give 3 talks in the UK on the 10th and 11th December 2018. Appearing at the Wellcome Genome Campus (Cambridge), the MRC Centre for Regenerative Medicine (Edinburgh) and at Guys Hospital (London)...
AMSBIO announces that induced pluripotent stem (iPS) cell expert - Dr Masato Nakagawa from the Nobel Prize winning Yamanaka Lab at the Centre for iPS Cell Research and Application, Kyoto University, Japan will give 3 talks in the UK on the 10th and 11th December 2018. Appearing at the Wellcome Genome Campus (Cambridge), the MRC Centre for Regenerative Medicine (Edinburgh) and at Guys Hospital (London)... AMSBIO has added an important new product to its immunotherapy range - a PD-L2 / TCR activator - CHO Recombinant Cell Line. PD-L2 is one of the key players in immune checkpoint therapy, which is the focus of the 2018 Nobel Prize for Physiology & Medicine . This work pioneered by Professor James P Allison from the USA and Professor Tasuku Honjo from Japan, has led to treatments for cancers, such as melanoma, lung cancer and others based upon immune checkpoint therapy...
AMSBIO has added an important new product to its immunotherapy range - a PD-L2 / TCR activator - CHO Recombinant Cell Line. PD-L2 is one of the key players in immune checkpoint therapy, which is the focus of the 2018 Nobel Prize for Physiology & Medicine . This work pioneered by Professor James P Allison from the USA and Professor Tasuku Honjo from Japan, has led to treatments for cancers, such as melanoma, lung cancer and others based upon immune checkpoint therapy... AMSBIO announce the launch of a new range of circulating tumor DNA (ctDNA) Reference Standards for cancer disease management research. A critical goal in cancer disease management is early detection. When detected early, cancer progression can be arrested using techniques such as targeted therapy, chemotherapy and surgery thereby increasing the chances of survival and a higher quality of life. Liquid biopsy offers the promise of providing a quick Liquid biopsy offers the promise of providing a quick, non-invasive and cost-effective alternative...
AMSBIO announce the launch of a new range of circulating tumor DNA (ctDNA) Reference Standards for cancer disease management research. A critical goal in cancer disease management is early detection. When detected early, cancer progression can be arrested using techniques such as targeted therapy, chemotherapy and surgery thereby increasing the chances of survival and a higher quality of life. Liquid biopsy offers the promise of providing a quick Liquid biopsy offers the promise of providing a quick, non-invasive and cost-effective alternative... AMSBIO produce a growing range of experimental cell lines, recombinant proteins and screening services to advance the search for new Chimeric Antigen Receptor (CAR T) cell therapies to treat cancers. For years, the foundations of cancer treatment were surgery, chemotherapy, and radiation therapy....
AMSBIO produce a growing range of experimental cell lines, recombinant proteins and screening services to advance the search for new Chimeric Antigen Receptor (CAR T) cell therapies to treat cancers. For years, the foundations of cancer treatment were surgery, chemotherapy, and radiation therapy.... The TUNR Flexible Gene Editing System from AMSBIO allows you to precisely control the expression of your gene of interest. Leveraging a CRISPR-Cas9 system for targeted integration of a polyA track at a precise location within the targeted gene, our kits are custom-designed for your project and include everything you need to tune gene expression in your favorite cell line. AMSBIO TUNR kits allow you to...
The TUNR Flexible Gene Editing System from AMSBIO allows you to precisely control the expression of your gene of interest. Leveraging a CRISPR-Cas9 system for targeted integration of a polyA track at a precise location within the targeted gene, our kits are custom-designed for your project and include everything you need to tune gene expression in your favorite cell line. AMSBIO TUNR kits allow you to... AMSBIO has announced an exosome isolation, manufacturing and characterization service to enable R&D groups to accelerate their discovery and development activities. Exosomes are small membrane vesicles with a size ranging from 40 to 100 nm. They are known to serve as functional mediators in cell interaction leading to cancer metastasis and have also been implicated in neurodegenerative diseases....
AMSBIO has announced an exosome isolation, manufacturing and characterization service to enable R&D groups to accelerate their discovery and development activities. Exosomes are small membrane vesicles with a size ranging from 40 to 100 nm. They are known to serve as functional mediators in cell interaction leading to cancer metastasis and have also been implicated in neurodegenerative diseases.... AMSBIO has introduced new CRISPR / Cas9 editing kits for gene knock-out, gene knock-in and gene mutation applications. The latest tool in genome science – CRISPR/Cas9 is a simple and efficient genome editing tool which allows for specific genome disruption and replacement resulting in high specificity and low cell toxicity.
AMSBIO has introduced new CRISPR / Cas9 editing kits for gene knock-out, gene knock-in and gene mutation applications. The latest tool in genome science – CRISPR/Cas9 is a simple and efficient genome editing tool which allows for specific genome disruption and replacement resulting in high specificity and low cell toxicity. AMSBIO announces MyEZGel™ 3D-iPSC Matrix - a powerful new tool for in vitro 3D human induced pluripotent stem cell (hiPSC) culture, enabling more accurate in vivo predictions in life science research and development. MyEZGel™ 3D-iPSC is a synthetic xeno-free hydrogel matrix inspired by muscle and spider silk proteins....
AMSBIO announces MyEZGel™ 3D-iPSC Matrix - a powerful new tool for in vitro 3D human induced pluripotent stem cell (hiPSC) culture, enabling more accurate in vivo predictions in life science research and development. MyEZGel™ 3D-iPSC is a synthetic xeno-free hydrogel matrix inspired by muscle and spider silk proteins.... ScreenIn3D (Glasgow, UK) is a new joint venture company set up by AMSBIO and the University of Strathclyde exploiting the latest advances in microfluidics and 3D culture to develop a novel microfluidic screening platform. he unique combination of microfluidic lab-on-a-chip technology with physiologically relevant 3D spheroids is designed to make drug discovery more closely relevant with what happens in the body...
ScreenIn3D (Glasgow, UK) is a new joint venture company set up by AMSBIO and the University of Strathclyde exploiting the latest advances in microfluidics and 3D culture to develop a novel microfluidic screening platform. he unique combination of microfluidic lab-on-a-chip technology with physiologically relevant 3D spheroids is designed to make drug discovery more closely relevant with what happens in the body... AMSBIO announces MyEZGel™ 3D-iPSC Matrix - a powerful new tool for in vitro 3D human induced pluripotent stem cell (hiPSC) culture, enabling more accurate in vivo predictions in life science research and development. MyEZGel™ 3D-iPSC is a synthetic xeno-free hydrogel matrix inspired by muscle and spider silk proteins. Beneficially, MyEZGel™ is proven to overcome basic problems associated with traditional...
AMSBIO announces MyEZGel™ 3D-iPSC Matrix - a powerful new tool for in vitro 3D human induced pluripotent stem cell (hiPSC) culture, enabling more accurate in vivo predictions in life science research and development. MyEZGel™ 3D-iPSC is a synthetic xeno-free hydrogel matrix inspired by muscle and spider silk proteins. Beneficially, MyEZGel™ is proven to overcome basic problems associated with traditional... AMSBIO announces the launch of StemFit® Basic03 clinical grade stem cell culture for regenerative medicine.
AMSBIO announces the launch of StemFit® Basic03 clinical grade stem cell culture for regenerative medicine.  AMSBIO, a global provider of gene editing and personalized medicine technologies, has launched a service for high throughput gene expression analysis. Based on the NanoString nCounter platform, the service works with a large array of sample types, including formats such as formalin-fixed paraffin-embedded (FFPE), which have been difficult to analyse by more traditional quantitative PCR...
AMSBIO, a global provider of gene editing and personalized medicine technologies, has launched a service for high throughput gene expression analysis. Based on the NanoString nCounter platform, the service works with a large array of sample types, including formats such as formalin-fixed paraffin-embedded (FFPE), which have been difficult to analyse by more traditional quantitative PCR... AMSBIO announces MC-Easy™ minicircle technology for labs looking to produce sustained transgene expression in model animal generation and gene therapy research without the risks of introducing exogenous DNA. Minicircles are circular DNA elements that no longer contain antibiotic resistance markers or the bacterial origin of replication....
AMSBIO announces MC-Easy™ minicircle technology for labs looking to produce sustained transgene expression in model animal generation and gene therapy research without the risks of introducing exogenous DNA. Minicircles are circular DNA elements that no longer contain antibiotic resistance markers or the bacterial origin of replication.... AMSBIO announces MC-Easy™ minicircle technology for labs looking to produce sustained transgene expression in model animal generation and gene therapy research without the risks of introducing exogenous DNA. Minicircles are circular DNA elements that no longer contain antibiotic resistance markers or the bacterial origin of replication....
AMSBIO announces MC-Easy™ minicircle technology for labs looking to produce sustained transgene expression in model animal generation and gene therapy research without the risks of introducing exogenous DNA. Minicircles are circular DNA elements that no longer contain antibiotic resistance markers or the bacterial origin of replication.... AMSBIO has signed an agreement with Genea Biocells (San Diego, USA) to become global distribution partner to the academic community for its groundbreaking skeletal muscle differentiation product range. Genea Biocells developed the world’s first protocol to robustly differentiate human pluripotent stem cells to skeletal muscle cells with high yields and without cell sorting or genetic manipulation (Caron et al. 2016)....
AMSBIO has signed an agreement with Genea Biocells (San Diego, USA) to become global distribution partner to the academic community for its groundbreaking skeletal muscle differentiation product range. Genea Biocells developed the world’s first protocol to robustly differentiate human pluripotent stem cells to skeletal muscle cells with high yields and without cell sorting or genetic manipulation (Caron et al. 2016).... AMSBIO reports on ground breaking research by the Institute for Research in Biomedicine (IRB), Barcelona that cites use of its proprietary 3D organoid technology to develop a mouse model that mimics advanced human colon cancer. This model has allowed them to study the immune system response for the first time. In a short space of time, therapies based on...
AMSBIO reports on ground breaking research by the Institute for Research in Biomedicine (IRB), Barcelona that cites use of its proprietary 3D organoid technology to develop a mouse model that mimics advanced human colon cancer. This model has allowed them to study the immune system response for the first time. In a short space of time, therapies based on... AMSBIO, a transatlantic life sciences company, and the University of Strathclyde (Glasgow, UK) have pioneered a multidisciplinary approach combining expertise in microfluidics and 3D culture to develop a novel microfluidic platform for cancer research. The new platform combines microfluidic lab-on-a-chip technology with physiologically relevant 3D spheroids to enable formation and long-term culture of 3D multicellular tumors / organoids for drug screening and...
AMSBIO, a transatlantic life sciences company, and the University of Strathclyde (Glasgow, UK) have pioneered a multidisciplinary approach combining expertise in microfluidics and 3D culture to develop a novel microfluidic platform for cancer research. The new platform combines microfluidic lab-on-a-chip technology with physiologically relevant 3D spheroids to enable formation and long-term culture of 3D multicellular tumors / organoids for drug screening and...
 AMSBIO has introduced recombinant Wnt3a with a new Wnt stabilizer that significantly extends the activity of this protein in serum-free medium from a half-life of just 2 hours to around 30 hours.
AMSBIO has introduced recombinant Wnt3a with a new Wnt stabilizer that significantly extends the activity of this protein in serum-free medium from a half-life of just 2 hours to around 30 hours. AMSBIO announces iMatrix recombinant Laminin-511 E8 fragments, an innovative cell culture matrix compatible with a wide variety of cell types, and exceptionally well suited for pluripotent stem cells.
AMSBIO announces iMatrix recombinant Laminin-511 E8 fragments, an innovative cell culture matrix compatible with a wide variety of cell types, and exceptionally well suited for pluripotent stem cells. iMatrix recombinant Laminin-511 E8 fragments is an innovative cell culture matrix compatible with a wide variety of cell types, and exceptionally well suited for pluripotent stem cells.
iMatrix recombinant Laminin-511 E8 fragments is an innovative cell culture matrix compatible with a wide variety of cell types, and exceptionally well suited for pluripotent stem cells. HSC-BANKER® from AMSBIO is a new optimised GMP grade cryopreservation medium for the banking of hematopoietic stem cells isolated from umbilical cord blood, peripheral blood and bone marrow.
HSC-BANKER® from AMSBIO is a new optimised GMP grade cryopreservation medium for the banking of hematopoietic stem cells isolated from umbilical cord blood, peripheral blood and bone marrow. AMSBIO has introduced a new range of Herpes Virus Entry Mediator (HVEM) products for use in immuno-oncology research.
AMSBIO has introduced a new range of Herpes Virus Entry Mediator (HVEM) products for use in immuno-oncology research. Traditional approaches for engineering changes in cellular expression profiles have employed mostly DNA or RNA based viral and non-viral vectors. Unfortunately, these methods carry high risks, due to genomic integration with permanent genetic alteration of cells....
Traditional approaches for engineering changes in cellular expression profiles have employed mostly DNA or RNA based viral and non-viral vectors. Unfortunately, these methods carry high risks, due to genomic integration with permanent genetic alteration of cells.... In both routine clinical use and diagnostic assay development, biologically-relevant positive and negative controls represent an invaluable resource. To ensure accuracy and reproducibility during IVD assay development and established diagnostic tests, reference standards for genomic DNA analysis and Immunohistochemistry....
In both routine clinical use and diagnostic assay development, biologically-relevant positive and negative controls represent an invaluable resource. To ensure accuracy and reproducibility during IVD assay development and established diagnostic tests, reference standards for genomic DNA analysis and Immunohistochemistry.... Stem cells and genome editing offer exciting opportunities within regenerative medicine. However, any clinical application of stem cells requires strict regulation to ensure that the cells are not exposed to animal derived products. StemFit® Basic02 is a xeno-free, defined medium for human pluripotent stem cell (hiPSC) culture....
Stem cells and genome editing offer exciting opportunities within regenerative medicine. However, any clinical application of stem cells requires strict regulation to ensure that the cells are not exposed to animal derived products. StemFit® Basic02 is a xeno-free, defined medium for human pluripotent stem cell (hiPSC) culture.... Attendees to the 2-day intensive course will receive world-class theoretical instruction and hands-on practical training from leaders in the field of Organoid technology. The course will also cover specialist approaches for the application of CRISPR gene editing technology to Organoid cultures....
Attendees to the 2-day intensive course will receive world-class theoretical instruction and hands-on practical training from leaders in the field of Organoid technology. The course will also cover specialist approaches for the application of CRISPR gene editing technology to Organoid cultures.... I-Stem was formed in 2005 through a collaboration between Inserm, the French National Institute of Health and Medical Research, and AFM-Telethon the French Association against Myopathies. I-Stem is the largest French laboratory for research and development dedicated to human pluripotent stem cells....
I-Stem was formed in 2005 through a collaboration between Inserm, the French National Institute of Health and Medical Research, and AFM-Telethon the French Association against Myopathies. I-Stem is the largest French laboratory for research and development dedicated to human pluripotent stem cells.... This product is a competitive ELISA-like kit using a recombinant Hyaluronic Acid Binding Protein (rHABP) optimized to quantify HA polymers of average molecular weight greater than 7.4 kDa in samples such as serum, plasma and culture supernatant....
This product is a competitive ELISA-like kit using a recombinant Hyaluronic Acid Binding Protein (rHABP) optimized to quantify HA polymers of average molecular weight greater than 7.4 kDa in samples such as serum, plasma and culture supernatant.... By targeted filtration of patient serum using a specific binding method removes protein contaminant to isolate exosome at 95% high purity. Using this proprietary filtration method, the purified tumor exosome does not contain any polymer or detergent (SDS, NP-40 or Triton). The purified tumor exosome can be used for RNA or protein analysis techniques such as qRT-PCR, microarray and mass spectrometry....
By targeted filtration of patient serum using a specific binding method removes protein contaminant to isolate exosome at 95% high purity. Using this proprietary filtration method, the purified tumor exosome does not contain any polymer or detergent (SDS, NP-40 or Triton). The purified tumor exosome can be used for RNA or protein analysis techniques such as qRT-PCR, microarray and mass spectrometry.... The CoolCLAVE™ Plus provides 20-25x more sterilization power than its popular predecessor (CoolCLAVE™) by using the power of combined UV and ozone cycles plus a new heating function. The CoolCLAVE™ Plus is highly effective in keeping sterile, or sterilizing contaminated pipettes, pipette tips, gloves, plates, small instruments as well as personal items such as keys, glasses and wallets....
The CoolCLAVE™ Plus provides 20-25x more sterilization power than its popular predecessor (CoolCLAVE™) by using the power of combined UV and ozone cycles plus a new heating function. The CoolCLAVE™ Plus is highly effective in keeping sterile, or sterilizing contaminated pipettes, pipette tips, gloves, plates, small instruments as well as personal items such as keys, glasses and wallets.... Immune evasion is one of the identifying hallmarks of cancer, and researchers worldwide are trying to identify the complex mechanisms that enable cancer cells to evade the host’s immune system. Cancer cells use the indoleamine 2,3-dioxygenase (IDO) pathway to suppress the host’s immune response in order to facilitate survival, growth, invasion, and metastasis of malignant cells....
Immune evasion is one of the identifying hallmarks of cancer, and researchers worldwide are trying to identify the complex mechanisms that enable cancer cells to evade the host’s immune system. Cancer cells use the indoleamine 2,3-dioxygenase (IDO) pathway to suppress the host’s immune response in order to facilitate survival, growth, invasion, and metastasis of malignant cells.... These pre-made products use a unique combination of transcription factor reporter technology coupled with lentiviral delivery to provide a simple, highly sensitive method capable of operating over a large dynamic range....
These pre-made products use a unique combination of transcription factor reporter technology coupled with lentiviral delivery to provide a simple, highly sensitive method capable of operating over a large dynamic range.... Data is presented that clearly shows that liver organoids recovered and grew well in STEM-CELLBANKER®–GMP, CELLBANKER® 1 and CELLBANKER® 2 freezing media after being thawed out after 2 days and 4-days cryopreservation....
Data is presented that clearly shows that liver organoids recovered and grew well in STEM-CELLBANKER®–GMP, CELLBANKER® 1 and CELLBANKER® 2 freezing media after being thawed out after 2 days and 4-days cryopreservation.... Multiple sclerosis (MS) is a demyelinating disease in which the insulating covers of nerve cells in the brain and spinal cord are damaged. MS is a debilitating neurological condition that affects 2.5 million patients worldwide, 100,000 in the UK with 200 new cases diagnosed each week in the US....
Multiple sclerosis (MS) is a demyelinating disease in which the insulating covers of nerve cells in the brain and spinal cord are damaged. MS is a debilitating neurological condition that affects 2.5 million patients worldwide, 100,000 in the UK with 200 new cases diagnosed each week in the US.... Circulating cfDNA is normally comprised of DNA fragments from healthy cells. However, apoptotic cells, necrotic cells, cancer cells, and intact cells all release cfDNA into the bloodstream. In addition, fetal cfDNA can be isolated from peripheral maternal blood. The utility and value of using cfDNA from serum and plasma for non-invasive molecular diagnostics.....
Circulating cfDNA is normally comprised of DNA fragments from healthy cells. However, apoptotic cells, necrotic cells, cancer cells, and intact cells all release cfDNA into the bloodstream. In addition, fetal cfDNA can be isolated from peripheral maternal blood. The utility and value of using cfDNA from serum and plasma for non-invasive molecular diagnostics..... Circulating cfDNA is normally comprised of DNA fragments from healthy cells. However, apoptotic cells, necrotic cells, cancer cells, and intact cells all release cfDNA into the bloodstream. In addition, fetal cfDNA can be isolated from peripheral maternal blood. The utility and value of using cfDNA from serum and plasma for non-invasive molecular diagnostics...
Circulating cfDNA is normally comprised of DNA fragments from healthy cells. However, apoptotic cells, necrotic cells, cancer cells, and intact cells all release cfDNA into the bloodstream. In addition, fetal cfDNA can be isolated from peripheral maternal blood. The utility and value of using cfDNA from serum and plasma for non-invasive molecular diagnostics... Proteoglycans are glycosylated proteins which contain covalently attached highly anionic glycosaminoglycans (GAGs). Proteoglycans are present in different forms within different types of extracellular matrices and connective tissues. Heparan sulfate proteoglycans (HSPGs) are known to play important structural and functional roles in linking the component proteins of the basement membrane...
Proteoglycans are glycosylated proteins which contain covalently attached highly anionic glycosaminoglycans (GAGs). Proteoglycans are present in different forms within different types of extracellular matrices and connective tissues. Heparan sulfate proteoglycans (HSPGs) are known to play important structural and functional roles in linking the component proteins of the basement membrane... Proteoglycans are glycosylated proteins which contain covalently attached highly anionic glycosaminoglycans (GAGs). Proteoglycans are present in different forms within different types of extracellular matrices and connective tissues. Heparan sulfate proteoglycans (HSPGs) are known to play important structural and functional roles in linking the component proteins of the basement membrane, controlling the permeability properties of the membranes and signal...
Proteoglycans are glycosylated proteins which contain covalently attached highly anionic glycosaminoglycans (GAGs). Proteoglycans are present in different forms within different types of extracellular matrices and connective tissues. Heparan sulfate proteoglycans (HSPGs) are known to play important structural and functional roles in linking the component proteins of the basement membrane, controlling the permeability properties of the membranes and signal... Alex Sim, Managing Director at AMSBIO said, "Our new partnership with Cellaria Biosciences expands our existing portfolio by introducing patient-derived cancer models; allowing customers to conduct research and drug discovery initiatives to advance precision medicine.” Directly derived from patient tumors without any genetic manipulation, these new products provide the assurance of primary cells....
Alex Sim, Managing Director at AMSBIO said, "Our new partnership with Cellaria Biosciences expands our existing portfolio by introducing patient-derived cancer models; allowing customers to conduct research and drug discovery initiatives to advance precision medicine.” Directly derived from patient tumors without any genetic manipulation, these new products provide the assurance of primary cells.... Cellular models are key tools that open the door to numerous neuroscience applications including neurodegeneration, neurogensis and developmental diseases. With the discovery that neural stem cells exist in the adult brain many researchers are now seeking to use these cells in in vitro studies....
Cellular models are key tools that open the door to numerous neuroscience applications including neurodegeneration, neurogensis and developmental diseases. With the discovery that neural stem cells exist in the adult brain many researchers are now seeking to use these cells in in vitro studies.... These viruses encode your chosen biosensor, either calcium or glutamate sensor and are ready for in vivo injection. The new range of Calcium or Glutamate biosensor products comes with a choice of promoter and the ability to include the Cre inducible (FLEx-ON) expression. AMSBIO have packaged these indicators into the most commonly used AAV serotypes (AAV8 and AAV9)...
These viruses encode your chosen biosensor, either calcium or glutamate sensor and are ready for in vivo injection. The new range of Calcium or Glutamate biosensor products comes with a choice of promoter and the ability to include the Cre inducible (FLEx-ON) expression. AMSBIO have packaged these indicators into the most commonly used AAV serotypes (AAV8 and AAV9)... Cellular metabolism involves a series of interconnected biochemical reactions catalyzed by enzymes inside a cell, better known as metabolic pathways. These reactions convert a substrate molecule or molecules through a series of metabolic intermediates, eventually yielding a final product....
Cellular metabolism involves a series of interconnected biochemical reactions catalyzed by enzymes inside a cell, better known as metabolic pathways. These reactions convert a substrate molecule or molecules through a series of metabolic intermediates, eventually yielding a final product.... Fatty acid oxidation is the primary metabolic pathway in a variety of tissues, which is particularly important during periods of glucose deprivation. In organs such as liver and skeletal muscle, FAO can provide over 75% of cellular ATP while in cardiac tissue it can be responsible for up to 90% of cellular energy requirements....
Fatty acid oxidation is the primary metabolic pathway in a variety of tissues, which is particularly important during periods of glucose deprivation. In organs such as liver and skeletal muscle, FAO can provide over 75% of cellular ATP while in cardiac tissue it can be responsible for up to 90% of cellular energy requirements.... Traditionally adult somatic tissues have proven difficult to expand in vitro, largely because of the complexity of recreating appropriate environmental signals in culture. Huch** and co-workers have overcome this problem and describe recently established protocols for the long-term (> 1 year) expansion and genetic manipulation of adult liver and pancreas cells in 3D organoid culture...
Traditionally adult somatic tissues have proven difficult to expand in vitro, largely because of the complexity of recreating appropriate environmental signals in culture. Huch** and co-workers have overcome this problem and describe recently established protocols for the long-term (> 1 year) expansion and genetic manipulation of adult liver and pancreas cells in 3D organoid culture... Killer-cell immunoglobulin-like receptors (KIRs), are a family of type I transmembrane glycoproteins expressed on the plasma membrane of Natural Killer (NK) cells and a minority of T cells. They regulate the killing function of these cells by interacting with major histocompatibility (MHC) class I molecules, which are expressed on all nucleated cell types. KIR receptors can distinguish between MHC class I allelic variants, which allows them to detect virally infected cells or...
Killer-cell immunoglobulin-like receptors (KIRs), are a family of type I transmembrane glycoproteins expressed on the plasma membrane of Natural Killer (NK) cells and a minority of T cells. They regulate the killing function of these cells by interacting with major histocompatibility (MHC) class I molecules, which are expressed on all nucleated cell types. KIR receptors can distinguish between MHC class I allelic variants, which allows them to detect virally infected cells or... Human endothelial progenitor cells are a primitive cell type. They are bone marrow derived cells with properties similar to embryonic angioblasts. Progenitor cells migrate into the blood stream and are able to differentiate into a variety of mature vascular endothelial cell types....
Human endothelial progenitor cells are a primitive cell type. They are bone marrow derived cells with properties similar to embryonic angioblasts. Progenitor cells migrate into the blood stream and are able to differentiate into a variety of mature vascular endothelial cell types.... Launched at the EMBO Symposium on Organoids: Modelling Organ Development and Disease in 3D Culture, the new 24-page handbook includes valuable information about the latest available products, protocols, example results and research paper citations. Within the protocols section detailed information is provided on a general submerged method for organoid culture, crypt organoid culture techniques...
Launched at the EMBO Symposium on Organoids: Modelling Organ Development and Disease in 3D Culture, the new 24-page handbook includes valuable information about the latest available products, protocols, example results and research paper citations. Within the protocols section detailed information is provided on a general submerged method for organoid culture, crypt organoid culture techniques... Wnt proteins are a family of cysteine-rich secreted polypeptides involved in important cell functions including cell to cell communication, cell proliferation, cell migration, cell polarity, survival and self-renewal. In particular Wnt3a signals play an important role in the ability of organoids to expand. Additionally, loss of activation of Wnt expression has been associated with alteration of cell fate, morphogenesis and mitogenesis which has considerable relevance in...
Wnt proteins are a family of cysteine-rich secreted polypeptides involved in important cell functions including cell to cell communication, cell proliferation, cell migration, cell polarity, survival and self-renewal. In particular Wnt3a signals play an important role in the ability of organoids to expand. Additionally, loss of activation of Wnt expression has been associated with alteration of cell fate, morphogenesis and mitogenesis which has considerable relevance in... Heparan Sulfate (HS) is synthesized as the glycosaminoglycan (GAG) component of heparan sulfate proteoglycans (HSPGs). It is expressed on the cell surface of virtually all cell types and basement membranes. It displays specific interactions with many biologically active proteins and, thus is involved in many important biological processes....
Heparan Sulfate (HS) is synthesized as the glycosaminoglycan (GAG) component of heparan sulfate proteoglycans (HSPGs). It is expressed on the cell surface of virtually all cell types and basement membranes. It displays specific interactions with many biologically active proteins and, thus is involved in many important biological processes.... The new MagSi-DNA Vegetal kit brings the convenience and cost effectiveness of magnetic bead technology to the world of plant genomics. Whether you work with DNA extracted from flowers, grain crops, fruits, vegetables, trees, or other plant materials, MagSi-DNA Vegetal is designed to maximize your effectiveness.....
The new MagSi-DNA Vegetal kit brings the convenience and cost effectiveness of magnetic bead technology to the world of plant genomics. Whether you work with DNA extracted from flowers, grain crops, fruits, vegetables, trees, or other plant materials, MagSi-DNA Vegetal is designed to maximize your effectiveness..... This new introduction extends the range of products offered by AMSBIO to support organoid culture. It will be of particular interest to the large number of leading research groups worldwide using BME 2 organoid matrix that specialise in drug screening applications....
This new introduction extends the range of products offered by AMSBIO to support organoid culture. It will be of particular interest to the large number of leading research groups worldwide using BME 2 organoid matrix that specialise in drug screening applications.... The Zika virus (ZIKV), which is borne by mosquitos, is causing worldwide concern because of its connection to a neurological birth disorder and its rapid spread across the globe. The imminent 2016 Olympic Games in Brazil, where the epidemic started, is as a consequence suffering withdrawals from a growing number of competitors....
The Zika virus (ZIKV), which is borne by mosquitos, is causing worldwide concern because of its connection to a neurological birth disorder and its rapid spread across the globe. The imminent 2016 Olympic Games in Brazil, where the epidemic started, is as a consequence suffering withdrawals from a growing number of competitors.... Targeted and precise genomic gene editing technologies are today key tools for genomic correction, modification and gene therapy. The recently discovered CRISPR/Cas gene editing technique offers higher targeting accuracy, much more target sequence selection, much less complexity and less off-target cell toxicity than the previous generation genome editing technologies. To enable CRISPR genomic editing, the AMSBIO kit...
Targeted and precise genomic gene editing technologies are today key tools for genomic correction, modification and gene therapy. The recently discovered CRISPR/Cas gene editing technique offers higher targeting accuracy, much more target sequence selection, much less complexity and less off-target cell toxicity than the previous generation genome editing technologies. To enable CRISPR genomic editing, the AMSBIO kit... The binding of PD-1, a receptor expressed on activated T-cells, to its ligands (PD-L1 and PD-L2) negatively regulates immune responses. PD-1 ligands are highly expressed in many cancers, and their interaction inhibits T-cell activity allowing cancer cells to escape immune surveillance. The PD-1: PD-Ligands pathway is also involved in regulating autoimmune responses, making these proteins promising therapeutic targets for...
The binding of PD-1, a receptor expressed on activated T-cells, to its ligands (PD-L1 and PD-L2) negatively regulates immune responses. PD-1 ligands are highly expressed in many cancers, and their interaction inhibits T-cell activity allowing cancer cells to escape immune surveillance. The PD-1: PD-Ligands pathway is also involved in regulating autoimmune responses, making these proteins promising therapeutic targets for... Human T-cell immunoreceptor with Ig and ITIM domains (TIGIT) is a receptor expressed on the surface of human T cells and NK cells that binds to CD155 and CD112 present on the surface of dendritic cells. The binding of TIGIT with CD155 or CD112 results in inhibition of T cell and NK cell activation....
Human T-cell immunoreceptor with Ig and ITIM domains (TIGIT) is a receptor expressed on the surface of human T cells and NK cells that binds to CD155 and CD112 present on the surface of dendritic cells. The binding of TIGIT with CD155 or CD112 results in inhibition of T cell and NK cell activation.... The binding of PD-1, a receptor expressed on activated T-cells, to its ligands (PD-L1 and PD-L2) negatively regulates immune responses. PD-1 ligands are highly expressed in many cancers, and their interaction inhibits T-cell activity allowing cancer cells to escape immune surveillance....
The binding of PD-1, a receptor expressed on activated T-cells, to its ligands (PD-L1 and PD-L2) negatively regulates immune responses. PD-1 ligands are highly expressed in many cancers, and their interaction inhibits T-cell activity allowing cancer cells to escape immune surveillance.... Formulated to be quick, affordable and easy to use, AMSBIO's new expanded suite of quantification kits, isolation tools, standards, DNA & RNA extraction kits, antibodies and cell culture reagents will facilitate your understanding of exosomes using a wide variety of samples. Exosomes are small endosome derived lipid nanoparticles actively secreted by exocytosis in most living cells. Release of exosomes occurs either constitutively or...
Formulated to be quick, affordable and easy to use, AMSBIO's new expanded suite of quantification kits, isolation tools, standards, DNA & RNA extraction kits, antibodies and cell culture reagents will facilitate your understanding of exosomes using a wide variety of samples. Exosomes are small endosome derived lipid nanoparticles actively secreted by exocytosis in most living cells. Release of exosomes occurs either constitutively or... Human T-cell immunoreceptor with Ig and ITIM domains (TIGIT) is a receptor expressed on the surface of human T cells and NK cells that binds to CD155 and CD112 present on the surface of dendritic cells. The binding of TIGIT with CD155 or CD112 results in inhibition of T cell and NK cell activation. Antibodies and other agents that inhibit this signaling pathway have known to increase the immune response, particularly...
Human T-cell immunoreceptor with Ig and ITIM domains (TIGIT) is a receptor expressed on the surface of human T cells and NK cells that binds to CD155 and CD112 present on the surface of dendritic cells. The binding of TIGIT with CD155 or CD112 results in inhibition of T cell and NK cell activation. Antibodies and other agents that inhibit this signaling pathway have known to increase the immune response, particularly... Formulated to be quick, affordable and easy to use, AMSBIO's new expanded suite of quantification kits, isolation tools, standards, DNA & RNA extraction kits, antibodies and cell culture reagents will facilitate your understanding of exosomes using a wide variety of samples. Exosomes are small endosome derived lipid nanoparticles actively secreted by exocytosis in most living cells. Release of exosomes occurs either constitutively or...
Formulated to be quick, affordable and easy to use, AMSBIO's new expanded suite of quantification kits, isolation tools, standards, DNA & RNA extraction kits, antibodies and cell culture reagents will facilitate your understanding of exosomes using a wide variety of samples. Exosomes are small endosome derived lipid nanoparticles actively secreted by exocytosis in most living cells. Release of exosomes occurs either constitutively or... Molecular oxygen is the key substrate of aerobic metabolism. Knowledge of cell oxygenation is therefore central to a detailed understanding of the cellular metabolic response to a particular treatment or manipulation. Traditionally intracellular measurements have proven very difficult, requiring the use of invasive, laborious, low-throughput, technically challenging techniques which in turn have limited the use of...
Molecular oxygen is the key substrate of aerobic metabolism. Knowledge of cell oxygenation is therefore central to a detailed understanding of the cellular metabolic response to a particular treatment or manipulation. Traditionally intracellular measurements have proven very difficult, requiring the use of invasive, laborious, low-throughput, technically challenging techniques which in turn have limited the use of... These new tools build upon the widespread use of AMSBIO’s BME2 ‘organoid matrix’ by leading research groups worldwide. BME 2 is the extracellular matrix of choice for growing and supporting organoid cultures that are increasingly being adopted in drug screening applications. A new R-Spondin1 cell line has been developed that provides a cost-effective solution by which labs can obtain a long-term supply of R-Spondin1...
These new tools build upon the widespread use of AMSBIO’s BME2 ‘organoid matrix’ by leading research groups worldwide. BME 2 is the extracellular matrix of choice for growing and supporting organoid cultures that are increasingly being adopted in drug screening applications. A new R-Spondin1 cell line has been developed that provides a cost-effective solution by which labs can obtain a long-term supply of R-Spondin1... These new tools build upon the widespread use of AMSBIO’s BME2 ‘organoid matrix’ by leading research groups worldwide. BME 2 is the extracellular matrix of choice for growing and supporting organoid cultures that are increasingly being adopted in drug screening applications. A new R-Spondin1 cell line has been developed that provides a cost-effective solution by which labs can obtain a long-term supply of R-Spondin1...
These new tools build upon the widespread use of AMSBIO’s BME2 ‘organoid matrix’ by leading research groups worldwide. BME 2 is the extracellular matrix of choice for growing and supporting organoid cultures that are increasingly being adopted in drug screening applications. A new R-Spondin1 cell line has been developed that provides a cost-effective solution by which labs can obtain a long-term supply of R-Spondin1... DNA damaging agents can promote aging, disease and cancer and are widespread in the environment as well as being produced within human cells as normal cellular metabolites. The ability to quantify DNA damage responses is consequently critical to researchers in public health, pharmaceutical or clinical labs. The CometChip® is based upon the well-established single cell gel electrophoresis “Comet Assay”, which...
DNA damaging agents can promote aging, disease and cancer and are widespread in the environment as well as being produced within human cells as normal cellular metabolites. The ability to quantify DNA damage responses is consequently critical to researchers in public health, pharmaceutical or clinical labs. The CometChip® is based upon the well-established single cell gel electrophoresis “Comet Assay”, which... Immunoassay Blocking Reagents (Blockers) are typically applied to ELISA and Lateral Flow-based assays, specifically paired monoclonal sandwich assays, competitive assays and antigen capture (IgG/IgM) assays. They work by removing interfering proteins in patient samples that could produce false results and an incorrect diagnosis. Choosing the best assay format depends on the intended application of the...
Immunoassay Blocking Reagents (Blockers) are typically applied to ELISA and Lateral Flow-based assays, specifically paired monoclonal sandwich assays, competitive assays and antigen capture (IgG/IgM) assays. They work by removing interfering proteins in patient samples that could produce false results and an incorrect diagnosis. Choosing the best assay format depends on the intended application of the... Despite significant advances in cancer research and treatments, the eradication of the disease remains elusive. This has led to a more urgent focus on precision medicine and advanced treatments like immunotherapy and the use of oncolytic viruses. Donor derived primary tumor cells offer a more in vivo like model potentially enhancing the development of targeted personalized therapeutics. It is known that using...
Despite significant advances in cancer research and treatments, the eradication of the disease remains elusive. This has led to a more urgent focus on precision medicine and advanced treatments like immunotherapy and the use of oncolytic viruses. Donor derived primary tumor cells offer a more in vivo like model potentially enhancing the development of targeted personalized therapeutics. It is known that using... Despite significant advances in cancer research and treatments, the eradication of the disease remains elusive. This has led to a more urgent focus on precision medicine and advanced treatments like immunotherapy and the use of oncolytic viruses. Donor derived primary tumor cells offer a more in vivo like model potentially enhancing the development of targeted personalized therapeutics. It is known that using immortalized...
Despite significant advances in cancer research and treatments, the eradication of the disease remains elusive. This has led to a more urgent focus on precision medicine and advanced treatments like immunotherapy and the use of oncolytic viruses. Donor derived primary tumor cells offer a more in vivo like model potentially enhancing the development of targeted personalized therapeutics. It is known that using immortalized... The new kit utilizes a highly efficient media based protocol to produce skeletal muscle cells from stem cells in a simple, scalable manner.
The new kit utilizes a highly efficient media based protocol to produce skeletal muscle cells from stem cells in a simple, scalable manner.  This new cell invasion assay is designed to enable cell movement through an extracellular matrix (ECM) in 3-Dimensions, thereby getting you as close as possible to an in vivo experiment using in vitro conditions. The invasion capacity of tumor cells is of particular concern in cancer research, and is a first step to metastasis, the deadliest aspect of the disease. Traditionally, cell invasion assays are performed by seeding cells in...
This new cell invasion assay is designed to enable cell movement through an extracellular matrix (ECM) in 3-Dimensions, thereby getting you as close as possible to an in vivo experiment using in vitro conditions. The invasion capacity of tumor cells is of particular concern in cancer research, and is a first step to metastasis, the deadliest aspect of the disease. Traditionally, cell invasion assays are performed by seeding cells in... Therapeutic antibody efficacy depends not only on the Fab fragment and its binding activity to the target antigen, but also depends on the Fc fragment and its interaction with key Fc receptors. As a consequence screening for desired binding affinity to the key Fc receptors is an essential component in the development of a high quality therapeutic mAb. Recombinant Fc Receptor proteins from AMSBIO are uniquely suitable for...
Therapeutic antibody efficacy depends not only on the Fab fragment and its binding activity to the target antigen, but also depends on the Fc fragment and its interaction with key Fc receptors. As a consequence screening for desired binding affinity to the key Fc receptors is an essential component in the development of a high quality therapeutic mAb. Recombinant Fc Receptor proteins from AMSBIO are uniquely suitable for... This new cell invasion assay is designed to enable cell movement through an extracellular matrix (ECM) in 3-Dimensions, thereby getting you as close as possible to an in vivo experiment using in vitro conditions.
This new cell invasion assay is designed to enable cell movement through an extracellular matrix (ECM) in 3-Dimensions, thereby getting you as close as possible to an in vivo experiment using in vitro conditions.  From the industry standard autophagy antibody APG8 (MAPLC3) to the newest autophagy antibodies such as LAMP and APG1, AMSBIO is able to provide the most relevant, qualified antibodies for autophagy research. Autophagy is a cellular process not only implicated in the death of a cell, but more widely implicated in the survival of a cell. Autophagy functions as a housekeeping mechanism through disposal of aging and/or dysfunctional proteins and organelles by isolating...
From the industry standard autophagy antibody APG8 (MAPLC3) to the newest autophagy antibodies such as LAMP and APG1, AMSBIO is able to provide the most relevant, qualified antibodies for autophagy research. Autophagy is a cellular process not only implicated in the death of a cell, but more widely implicated in the survival of a cell. Autophagy functions as a housekeeping mechanism through disposal of aging and/or dysfunctional proteins and organelles by isolating... Featuring over 1,240 pre-packaged human miRNA precursor adenoviruses and 30,000 pre-packaged human full-length cDNA ORF adenoviruses the collection will considerably enhance high throughput drug discovery, improve functional genomic studies, and make life science research more cost-effective and efficient.
Featuring over 1,240 pre-packaged human miRNA precursor adenoviruses and 30,000 pre-packaged human full-length cDNA ORF adenoviruses the collection will considerably enhance high throughput drug discovery, improve functional genomic studies, and make life science research more cost-effective and efficient.  To make selection of the optimum lentivirus quick and easy, AMSBIO has developed an
To make selection of the optimum lentivirus quick and easy, AMSBIO has developed an  Since its emergence, CRISPR-Cas9 technology has been rapidly adopted as a mainstream approach for performing genetic manipulation. This powerful tool has transformed the process of generating “footprint-free” cellular models for studying genetic diseases. Using this approach, researchers can easily generate disease-relevant isogenic models to determine the impact of correcting or introducing disease-relevant mutations on cellular...
Since its emergence, CRISPR-Cas9 technology has been rapidly adopted as a mainstream approach for performing genetic manipulation. This powerful tool has transformed the process of generating “footprint-free” cellular models for studying genetic diseases. Using this approach, researchers can easily generate disease-relevant isogenic models to determine the impact of correcting or introducing disease-relevant mutations on cellular... To make selection of the optimum lentivirus quick and easy, AMSBIO has developed an
To make selection of the optimum lentivirus quick and easy, AMSBIO has developed an  RPLs are enhanced glycoselective bioaffinity proteins that enable efficient detection, analysis and selective isolation of glycosylated biomolecules. RPLs offer many advantages over traditional plant and eukaryotic lectins. They also offer many advantages over current glycoanalytical and chromatographic methodologies that are not glycoselective or require prior release of glycans which results in the sample destruction. Recombinant...
RPLs are enhanced glycoselective bioaffinity proteins that enable efficient detection, analysis and selective isolation of glycosylated biomolecules. RPLs offer many advantages over traditional plant and eukaryotic lectins. They also offer many advantages over current glycoanalytical and chromatographic methodologies that are not glycoselective or require prior release of glycans which results in the sample destruction. Recombinant... Methylation is involved in nearly every aspect of life. SAM is the sole methyl donor for a variety of methyl-transfer reactions in DNA, RNA, proteins, lipids, phosphilipids, hormones and neurotransmitters. Proper DNA methylation is essential for normal embryonic development. However, when the methyl-transferase gene is homozygously deleted, it is lethal. DNA improperly methylated has been found in many tumors. Alterations in...
Methylation is involved in nearly every aspect of life. SAM is the sole methyl donor for a variety of methyl-transfer reactions in DNA, RNA, proteins, lipids, phosphilipids, hormones and neurotransmitters. Proper DNA methylation is essential for normal embryonic development. However, when the methyl-transferase gene is homozygously deleted, it is lethal. DNA improperly methylated has been found in many tumors. Alterations in... Immunotherapy for the treatment of cancer is rapidly evolving from therapies that globally and non-specifically simulate the immune system to more targeted activation of individual components of the immune system. The net result of this targeted approach is decreased toxicity and increased efficacy of immunotherapy. The understanding of the checkpoint signalling pathway involving the programmed death 1 (PD-1) receptor and its ligands (PD-L1/2) in...
Immunotherapy for the treatment of cancer is rapidly evolving from therapies that globally and non-specifically simulate the immune system to more targeted activation of individual components of the immune system. The net result of this targeted approach is decreased toxicity and increased efficacy of immunotherapy. The understanding of the checkpoint signalling pathway involving the programmed death 1 (PD-1) receptor and its ligands (PD-L1/2) in... There is a definite need for more predictive in vitro efficacy assays to reduce both the number of costly drug failures in clinical trials and the number of animals used in pre-clinical testing. Performing certain cell-based assays in 3D has proven to improve their relevance as models; however, when choosing support for the cell culture growth, important factors to consider are: reproducibility of the environment, similarity to the real-life conditions, ease of...
There is a definite need for more predictive in vitro efficacy assays to reduce both the number of costly drug failures in clinical trials and the number of animals used in pre-clinical testing. Performing certain cell-based assays in 3D has proven to improve their relevance as models; however, when choosing support for the cell culture growth, important factors to consider are: reproducibility of the environment, similarity to the real-life conditions, ease of... PATHM2 libraries are available to identify accessory molecules that improve cell viability, proliferation or yields. All compounds are hand selected to address ‘traditional’ cascades that play a role in pluripotency maintenance or specific differentiation. Multiple agents are included to interrogate new and emerging networks/targets relevant to stem cell biology. PATHM2 kits are also available to screen your disease model and identify/confirm critical...
PATHM2 libraries are available to identify accessory molecules that improve cell viability, proliferation or yields. All compounds are hand selected to address ‘traditional’ cascades that play a role in pluripotency maintenance or specific differentiation. Multiple agents are included to interrogate new and emerging networks/targets relevant to stem cell biology. PATHM2 kits are also available to screen your disease model and identify/confirm critical... Adeno-associated viruses are single-stranded DNA viruses that can infect a broad range of cell types including dividing and non-dividing cells and are, therefore, widely used vehicles for gene delivery. Clinical trials have not only found AAV to be consistently safe and stable, but their vectors are capable of causing long-term expression in human cells. Therefore, AAV vectors have many advantages that many other vectors do not. To date, recombinant AAV...
Adeno-associated viruses are single-stranded DNA viruses that can infect a broad range of cell types including dividing and non-dividing cells and are, therefore, widely used vehicles for gene delivery. Clinical trials have not only found AAV to be consistently safe and stable, but their vectors are capable of causing long-term expression in human cells. Therefore, AAV vectors have many advantages that many other vectors do not. To date, recombinant AAV... Made using a patent-pending process, CellMax™ Cell Pellet Slides have a highly consistent density and homogeneity across the entire cell pellet block that ensures you get accurate results time after time. Cells are harvested by a proprietary trypsin-free method preserving cell surface antigens and inflicting minimal physical damage that could lead to a loss of biomarkers. CellMax™ slides produce accurate and reproducible results for immunohistochemistry...
Made using a patent-pending process, CellMax™ Cell Pellet Slides have a highly consistent density and homogeneity across the entire cell pellet block that ensures you get accurate results time after time. Cells are harvested by a proprietary trypsin-free method preserving cell surface antigens and inflicting minimal physical damage that could lead to a loss of biomarkers. CellMax™ slides produce accurate and reproducible results for immunohistochemistry... Made using a patent-pending process, CellMax™ Cell Pellet Slides have a highly consistent density and homogeneity across the entire cell pellet block that ensures you get accurate results time after time. Cells are harvested by a proprietary trypsin-free method preserving cell surface antigens and inflicting minimal physical damage that could lead to a loss of biomarkers. CellMax™ slides produce accurate and reproducible results...
Made using a patent-pending process, CellMax™ Cell Pellet Slides have a highly consistent density and homogeneity across the entire cell pellet block that ensures you get accurate results time after time. Cells are harvested by a proprietary trypsin-free method preserving cell surface antigens and inflicting minimal physical damage that could lead to a loss of biomarkers. CellMax™ slides produce accurate and reproducible results... BioPORTER Protein Delivery Reagent is a unique lipid formulation that allows direct translocation of proteins into living cells. Neurodegenerative tauopathies, including Alzheimer disease and frontotemporal dementias, are characterized by neurofibrillary tangles (NFT) composed of intracellular hyperphosphorylated Tau aggregates. Predominantly expressed in neurons, Tau is a microtubule (MT)-binding protein that stabilizes and promotes the assembly...
BioPORTER Protein Delivery Reagent is a unique lipid formulation that allows direct translocation of proteins into living cells. Neurodegenerative tauopathies, including Alzheimer disease and frontotemporal dementias, are characterized by neurofibrillary tangles (NFT) composed of intracellular hyperphosphorylated Tau aggregates. Predominantly expressed in neurons, Tau is a microtubule (MT)-binding protein that stabilizes and promotes the assembly... BioPORTER Protein Delivery Reagent is a unique lipid formulation that allows direct translocation of proteins into living cells. Neurodegenerative tauopathies, including Alzheimer disease and frontotemporal dementias, are characterized by neurofibrillary tangles (NFT) composed of intracellular hyperphosphorylated Tau aggregates. Predominantly expressed in neurons, Tau is a microtubule (MT)-binding protein that stabilizes and promotes the...
BioPORTER Protein Delivery Reagent is a unique lipid formulation that allows direct translocation of proteins into living cells. Neurodegenerative tauopathies, including Alzheimer disease and frontotemporal dementias, are characterized by neurofibrillary tangles (NFT) composed of intracellular hyperphosphorylated Tau aggregates. Predominantly expressed in neurons, Tau is a microtubule (MT)-binding protein that stabilizes and promotes the... Derived from placental and adipose derived stem cells, to ensure consistent high quality, these new products are ideally suited for research involving wound healing, stem cell differentiation and tissue regeneration. Exosomes are small vesicles (30–150 nm) containing sophisticated RNA and protein cargos. They are secreted by all cell types in culture and are found to occur naturally in body fluids, including blood, saliva, urine, CSF, and breast milk. The precise molecular mechanics for...
Derived from placental and adipose derived stem cells, to ensure consistent high quality, these new products are ideally suited for research involving wound healing, stem cell differentiation and tissue regeneration. Exosomes are small vesicles (30–150 nm) containing sophisticated RNA and protein cargos. They are secreted by all cell types in culture and are found to occur naturally in body fluids, including blood, saliva, urine, CSF, and breast milk. The precise molecular mechanics for... Supplied as a ready-to-use formulation, STEM-CELLBANKER is a chemically defined freezing solution optimised for stem cell and iPS cell storage as well as preservation of other valuable cells. Recent data** supports its unmatched ability for use in cryopreservation of tissues. It is completely free of serum and animal derived component, and contains only US Pharmacopeia, European Pharmacopeia or Japanese Pharmacopeia graded ingredients...
Supplied as a ready-to-use formulation, STEM-CELLBANKER is a chemically defined freezing solution optimised for stem cell and iPS cell storage as well as preservation of other valuable cells. Recent data** supports its unmatched ability for use in cryopreservation of tissues. It is completely free of serum and animal derived component, and contains only US Pharmacopeia, European Pharmacopeia or Japanese Pharmacopeia graded ingredients... Organoids, small clusters of cells that accurately mimic the behaviour of human tissue, can be used to test cancer drugs and, eventually, to identify effective personalised treatments for patients.
Organoids, small clusters of cells that accurately mimic the behaviour of human tissue, can be used to test cancer drugs and, eventually, to identify effective personalised treatments for patients.  The TrueORF product line is a new generation of cDNA clone products that enables expression of the encoded transcript as a tagged protein. This facilitates multiple downstream applications that utilize an anti-tag antibody (Myc-DDK or GFP) including protein detection, protein purification, subcellular localization, and others. TrueORFs not only provide an instant solution for tagged protein expression but also offer the flexibility that they...
The TrueORF product line is a new generation of cDNA clone products that enables expression of the encoded transcript as a tagged protein. This facilitates multiple downstream applications that utilize an anti-tag antibody (Myc-DDK or GFP) including protein detection, protein purification, subcellular localization, and others. TrueORFs not only provide an instant solution for tagged protein expression but also offer the flexibility that they... Unlike most of other commercially available cytokine products, ActiveMax® cytokines are expressed exclusively in human cells under strict animal-free and xeno-free conditions. Therefore, they are uniquely suitable for human cell culture and assay development. Endotoxin and other non–human components can provoke immune response in human systems. These contaminations are significant complicating factors for human cell culture experiments, in particular...
Unlike most of other commercially available cytokine products, ActiveMax® cytokines are expressed exclusively in human cells under strict animal-free and xeno-free conditions. Therefore, they are uniquely suitable for human cell culture and assay development. Endotoxin and other non–human components can provoke immune response in human systems. These contaminations are significant complicating factors for human cell culture experiments, in particular... Attaching biotin to proteins and other macromolecules is an established labelling method which allows specific detection of biotin-tagged molecules via anti-biotin antibody, avidin or streptavidin based reporter systems. Biotinylation reagents are available for targeting specific functional groups or residues, including primary amines, sulfhydryls, carboxyls and carbohydrates. Photoreactive biotin compounds that react nonspecifically...
Attaching biotin to proteins and other macromolecules is an established labelling method which allows specific detection of biotin-tagged molecules via anti-biotin antibody, avidin or streptavidin based reporter systems. Biotinylation reagents are available for targeting specific functional groups or residues, including primary amines, sulfhydryls, carboxyls and carbohydrates. Photoreactive biotin compounds that react nonspecifically... Organoids are organ-like structures that can be formed by 3D cell culture and differentiation of stem cells or organ progenitors. Organoids are capable of recapitulating aspects of organ function in in vitro. The current research and therapeutic potential of organoids include organogenesis models, drug testing, tumor / disease models, toxicity screening, personalised medicine and regenerative medicine / organ replacement. BME 2 reduced growth...
Organoids are organ-like structures that can be formed by 3D cell culture and differentiation of stem cells or organ progenitors. Organoids are capable of recapitulating aspects of organ function in in vitro. The current research and therapeutic potential of organoids include organogenesis models, drug testing, tumor / disease models, toxicity screening, personalised medicine and regenerative medicine / organ replacement. BME 2 reduced growth... Together with new indoleamine 2,3-dioxygenase (IDO) assay kits these products that can be used to screen for inhibitors of protein-protein interaction, as well as neutralizing antibodies that serve as positive controls for inhibition. Immune evasion is one of the identifying hallmarks of cancer, and researchers are trying to identify the complex mechanisms that enable cancer cells to evade the host’s immune system. Cancer cells use the...
Together with new indoleamine 2,3-dioxygenase (IDO) assay kits these products that can be used to screen for inhibitors of protein-protein interaction, as well as neutralizing antibodies that serve as positive controls for inhibition. Immune evasion is one of the identifying hallmarks of cancer, and researchers are trying to identify the complex mechanisms that enable cancer cells to evade the host’s immune system. Cancer cells use the... Offering high transfection efficiency and expression levels across a broad range of cell types, including stem cells and primary cells, mRNA-In™ is a robust and easy-to-use mRNA delivery solution proven in applications including protein expression and iPSC-reprogramming. Recognized as among the most difficult cell types to transfect, either freshly isolated or cryopreserved neurons or neural stem cells can be transfected with...
Offering high transfection efficiency and expression levels across a broad range of cell types, including stem cells and primary cells, mRNA-In™ is a robust and easy-to-use mRNA delivery solution proven in applications including protein expression and iPSC-reprogramming. Recognized as among the most difficult cell types to transfect, either freshly isolated or cryopreserved neurons or neural stem cells can be transfected with... Offering high transfection efficiency and expression levels across a broad range of cell types, including stem cells and primary cells, mRNA-In™ is a robust and easy-to-use mRNA delivery solution proven in applications including protein expression and iPSC-reprogramming. Recognized as among the most difficult cell types to transfect, either freshly isolated or cryopreserved neurons or neural stem cells can be transfected with...
Offering high transfection efficiency and expression levels across a broad range of cell types, including stem cells and primary cells, mRNA-In™ is a robust and easy-to-use mRNA delivery solution proven in applications including protein expression and iPSC-reprogramming. Recognized as among the most difficult cell types to transfect, either freshly isolated or cryopreserved neurons or neural stem cells can be transfected with... In recent news, AstraZeneca reported upon how their ovarian cancer drug Lynparza™ (olaparib) is the first PARP inhibitor to be granted approval by the European Commission and the US Food and Drug Administration (FDA)**. This has led to a surge of interest in this class of drugs, which can exploit tumour DNA repair pathway deficiencies to preferentially kill cancer cells. Dr William Hadlington-Booth of AMSBIO commented "Our High Throughput PARP in vivo...
In recent news, AstraZeneca reported upon how their ovarian cancer drug Lynparza™ (olaparib) is the first PARP inhibitor to be granted approval by the European Commission and the US Food and Drug Administration (FDA)**. This has led to a surge of interest in this class of drugs, which can exploit tumour DNA repair pathway deficiencies to preferentially kill cancer cells. Dr William Hadlington-Booth of AMSBIO commented "Our High Throughput PARP in vivo... These results open up new experimental avenues towards the use of human liver material expanded in vitro as an alternative cell source for disease modeling, toxicology studies, drug testing, regenerative medicine and gene therapy. Liver diseases (ranging from genetic inherited disorders to viral hepatitis, liver cancer, and obesity-related fatty liver disease) are the twelfth-leading cause of death in the United States. Failure in the management of...
These results open up new experimental avenues towards the use of human liver material expanded in vitro as an alternative cell source for disease modeling, toxicology studies, drug testing, regenerative medicine and gene therapy. Liver diseases (ranging from genetic inherited disorders to viral hepatitis, liver cancer, and obesity-related fatty liver disease) are the twelfth-leading cause of death in the United States. Failure in the management of... Screening of candidate antibodies against greater than 10,000 human proteins, using a state-of-the-art High Density Protein Microarray Platform, has resulted in the identification of the most specific monoclonal antibodies (UltraMAB antibodies) available for cancer biomarkers and other important diagnostic targets. Performance and specificity are key pre-requisites for antibodies to be used for diagnostic and therapeutic applications. To ensure...
Screening of candidate antibodies against greater than 10,000 human proteins, using a state-of-the-art High Density Protein Microarray Platform, has resulted in the identification of the most specific monoclonal antibodies (UltraMAB antibodies) available for cancer biomarkers and other important diagnostic targets. Performance and specificity are key pre-requisites for antibodies to be used for diagnostic and therapeutic applications. To ensure... Neurons are among the most difficult cell types to transfect. DNA-In™ Neuro Transfection Reagent offers researchers a cost effective, robust and easy-to-use DNA delivery solution for transfecting freshly isolated and cryopreserved neurons. DNA-In™ Neuro Transfection Reagent reproducibly transfects neurons and neural stem cells at optimal efficiency with exceptionally low toxicity to support uncompromised post-transfection assays...
Neurons are among the most difficult cell types to transfect. DNA-In™ Neuro Transfection Reagent offers researchers a cost effective, robust and easy-to-use DNA delivery solution for transfecting freshly isolated and cryopreserved neurons. DNA-In™ Neuro Transfection Reagent reproducibly transfects neurons and neural stem cells at optimal efficiency with exceptionally low toxicity to support uncompromised post-transfection assays... The new products comprise 3 different monoclonal antibodies to the Ebola virus and 2 recombinant proteins (from the Sudan and Zaire strains) suitable for use in producing an optimised ELISA test kit for Ebola. An antigen-capture enzyme-linked immunosorbant assay (ELISA) test for Ebola offers the possibility of diagnosis within the first few days after symptoms begin. Ebola, also known as Ebola hemorrhagic fever, is a disease that typically...
The new products comprise 3 different monoclonal antibodies to the Ebola virus and 2 recombinant proteins (from the Sudan and Zaire strains) suitable for use in producing an optimised ELISA test kit for Ebola. An antigen-capture enzyme-linked immunosorbant assay (ELISA) test for Ebola offers the possibility of diagnosis within the first few days after symptoms begin. Ebola, also known as Ebola hemorrhagic fever, is a disease that typically... MagSi-Direct provides a convenient and efficient way to attach virtually any biomolecule to nanoscopic paramagnetic beads. It is particularly suited for exploiting interactions between a biomolecule and its binding partners. With MagSi-Direct, you can start with a molecule of interest, attach magnetic beads to it, and then use a magnet to isolate that molecule from any desired reaction mixture, together with any other molecules, complexes, or even intact cells to which the starting molecule has bound....
MagSi-Direct provides a convenient and efficient way to attach virtually any biomolecule to nanoscopic paramagnetic beads. It is particularly suited for exploiting interactions between a biomolecule and its binding partners. With MagSi-Direct, you can start with a molecule of interest, attach magnetic beads to it, and then use a magnet to isolate that molecule from any desired reaction mixture, together with any other molecules, complexes, or even intact cells to which the starting molecule has bound....
 This service includes synthesis of phosphorylated and non-phosphorylated peptides, conjugation to a carrier protein, immunization, serum production and a 2-step affinity purification of the antibodies. To ensure absolute specificity for each phosphorylated amino acid a stringent dot blot testing regime is carried out guaranteeing that for all projects the phospho peptide is preferentially recognized. A complete package of non-phosphorylated and phosphorylated peptides, pre-immune sera and...
This service includes synthesis of phosphorylated and non-phosphorylated peptides, conjugation to a carrier protein, immunization, serum production and a 2-step affinity purification of the antibodies. To ensure absolute specificity for each phosphorylated amino acid a stringent dot blot testing regime is carried out guaranteeing that for all projects the phospho peptide is preferentially recognized. A complete package of non-phosphorylated and phosphorylated peptides, pre-immune sera and... MagSi-NGSPREP supports all standard DNA clean-up protocols encountered during Next-Gen library preparation, including the classical one-sided and two-sided "solid phase reversible immobilization" (SPRI) size selection protocols. The simple and flexible protocols employed using MagSi-NGSPREP can be adjusted to your specific application and NGS platform. MagSi-NGSPREP can be used manually but is also easy to automate fo...
MagSi-NGSPREP supports all standard DNA clean-up protocols encountered during Next-Gen library preparation, including the classical one-sided and two-sided "solid phase reversible immobilization" (SPRI) size selection protocols. The simple and flexible protocols employed using MagSi-NGSPREP can be adjusted to your specific application and NGS platform. MagSi-NGSPREP can be used manually but is also easy to automate fo... These neural cells are derived using integration-free, fully defined neural induction conditions. AMSBIO neural cells are capable of generating a spectrum of cortical neurons that are electrically active and have the ability to form functional synapses and circuits in vitro. Cerebral cortical neurons are implicated in numerous neurological diseases including Alzheimer's disease, autism, epilepsy and stroke. Despite strong interest in these diseases, high quality human in...
These neural cells are derived using integration-free, fully defined neural induction conditions. AMSBIO neural cells are capable of generating a spectrum of cortical neurons that are electrically active and have the ability to form functional synapses and circuits in vitro. Cerebral cortical neurons are implicated in numerous neurological diseases including Alzheimer's disease, autism, epilepsy and stroke. Despite strong interest in these diseases, high quality human in... Measuring just 13 x 11 x 5 inches (32 x 28 x 13 cm), it will fit in most standard laboratory cell culture incubators, air incubators, cell culture hoods, PCR hoods, or any other environment where a sterile atmosphere is critical. Following simple operational instructions the Ozilla™ is able to completely eliminate airborne as well as surface contaminants and germs including bacteria, phage, and fungus...
Measuring just 13 x 11 x 5 inches (32 x 28 x 13 cm), it will fit in most standard laboratory cell culture incubators, air incubators, cell culture hoods, PCR hoods, or any other environment where a sterile atmosphere is critical. Following simple operational instructions the Ozilla™ is able to completely eliminate airborne as well as surface contaminants and germs including bacteria, phage, and fungus... CRISPR/Cas9 is revolutionizing the field of genomic editing by providing scientists with a powerful tool able to change any gene, in any cell in a highly targeted manner and without introducing foreign DNA. The benefits of CRISPR/Cas9 over previous forms of gene editing, such as TALENs and zinc finger, are that it is much simpler to implement and has higher efficiency at performing bi-allelic gene modifications...
CRISPR/Cas9 is revolutionizing the field of genomic editing by providing scientists with a powerful tool able to change any gene, in any cell in a highly targeted manner and without introducing foreign DNA. The benefits of CRISPR/Cas9 over previous forms of gene editing, such as TALENs and zinc finger, are that it is much simpler to implement and has higher efficiency at performing bi-allelic gene modifications...
 Over the past two decades, many researchers have actively sought ways to culture cells in 3D. The conclusion reached by many researchers is that there is no single optimal solution, each cell type needs a different environment and many biological processes may need specific methods to study them. Leading the field in the provision of solutions for 3D Cell Culture, AMSBIO’s scientists have distilled the best technologies into a useful guide....
Over the past two decades, many researchers have actively sought ways to culture cells in 3D. The conclusion reached by many researchers is that there is no single optimal solution, each cell type needs a different environment and many biological processes may need specific methods to study them. Leading the field in the provision of solutions for 3D Cell Culture, AMSBIO’s scientists have distilled the best technologies into a useful guide....







 Commenting on the new agreement Phillip Pridham-Field of AMSBIO said "Sanguine's approach to biospecimen collection and their high patient retention allow researchers to collect the data they need with better turnaround time and with the potential for longitudinal studies. We believe their extensive biospecimen library will be an excellent addition to our current product offerings for researchers in life sciences...
Commenting on the new agreement Phillip Pridham-Field of AMSBIO said "Sanguine's approach to biospecimen collection and their high patient retention allow researchers to collect the data they need with better turnaround time and with the potential for longitudinal studies. We believe their extensive biospecimen library will be an excellent addition to our current product offerings for researchers in life sciences...

 Using AMSBIO ExpressArt® RNA isolation technology it is now possible to achieve high RNA yield and maximum sequence length from FFPE or LCM samples without the paraffin removal step. ExpressArt® RNA technology overcomes traditional limitations placed on research due to limited sample size, RNA degradation and interference from the crosslinking in FFPE samples.
Using AMSBIO ExpressArt® RNA isolation technology it is now possible to achieve high RNA yield and maximum sequence length from FFPE or LCM samples without the paraffin removal step. ExpressArt® RNA technology overcomes traditional limitations placed on research due to limited sample size, RNA degradation and interference from the crosslinking in FFPE samples. 


 The new AMSBIO 3D Spheroid Proliferation/Viability Assay provides a useful tool for modeling tumor response in vitro. The kit utilises a 3D Culture Qualified 96 Well Spheroid Formation Plate alongside a specialised Spheroid Formation Extracellular Matrix to drive aggregation and/or spheroid formation of cells. Upon completion of spheroid formation, the spheroid may be treated with pharmacological agents to evaluate tumor viability after drug treatment...
The new AMSBIO 3D Spheroid Proliferation/Viability Assay provides a useful tool for modeling tumor response in vitro. The kit utilises a 3D Culture Qualified 96 Well Spheroid Formation Plate alongside a specialised Spheroid Formation Extracellular Matrix to drive aggregation and/or spheroid formation of cells. Upon completion of spheroid formation, the spheroid may be treated with pharmacological agents to evaluate tumor viability after drug treatment...
 Drawing upon a wealth of experience of working with a wide range of 3D cell culture procedures and formats the guide is aimed at assisting research scientists looking to culture cells in more physiologically relevant environments. Traditional monolayer cell culture on plastic dishes or in flasks, rarely recreates the conditions cells experience in vivo. Over the past 20 years, many researchers have actively sought ways to culture cells in 3D...
Drawing upon a wealth of experience of working with a wide range of 3D cell culture procedures and formats the guide is aimed at assisting research scientists looking to culture cells in more physiologically relevant environments. Traditional monolayer cell culture on plastic dishes or in flasks, rarely recreates the conditions cells experience in vivo. Over the past 20 years, many researchers have actively sought ways to culture cells in 3D...
 Collagen Antibody-Induced Arthritis (CAIA) has been widely used since 1998 when 4-clone cocktail (Arthrogen-CIA® arthritogenic monoclonal antibodies) kits first appeared. In order to induce consistent arthritis more effectively in various mouse strains including CAIA low responder C57BL/6 mice, and a variety of unpredictable knockout and transgenic mice with C57BL/6 (H-2b) or 129/Sv (H-2b) backgrounds, a new 5-clone cocktail kits have been developed by adding a new clone to the 4-clone cocktail...
Collagen Antibody-Induced Arthritis (CAIA) has been widely used since 1998 when 4-clone cocktail (Arthrogen-CIA® arthritogenic monoclonal antibodies) kits first appeared. In order to induce consistent arthritis more effectively in various mouse strains including CAIA low responder C57BL/6 mice, and a variety of unpredictable knockout and transgenic mice with C57BL/6 (H-2b) or 129/Sv (H-2b) backgrounds, a new 5-clone cocktail kits have been developed by adding a new clone to the 4-clone cocktail... AMSBIO has added cancer and normal tissue cDNA arrays to its cDNA range which also includes individual PCR-ready first strand samples and panels. The cDNA in each array is synthesized from high quality total RNA from pathologically-verified tissues. Each array is provided with clinical information and QC data that has been both normalized and validated with ß-actin in two sequential qPCR analyses...
AMSBIO has added cancer and normal tissue cDNA arrays to its cDNA range which also includes individual PCR-ready first strand samples and panels. The cDNA in each array is synthesized from high quality total RNA from pathologically-verified tissues. Each array is provided with clinical information and QC data that has been both normalized and validated with ß-actin in two sequential qPCR analyses...
 Containing nearly 300 biomimetics of Fibronectin, Vitronectin, Laminin and Collagen, for coating plates or creating 3D culture scaffolds, AMSBIO's new ECM combinatorial library provides a powerful tool for identifying the cellular adhesion profile of your cell line or tumour against the widest commercially available collection of cell surface receptor binding peptide motifs...
Containing nearly 300 biomimetics of Fibronectin, Vitronectin, Laminin and Collagen, for coating plates or creating 3D culture scaffolds, AMSBIO's new ECM combinatorial library provides a powerful tool for identifying the cellular adhesion profile of your cell line or tumour against the widest commercially available collection of cell surface receptor binding peptide motifs...
 In the article the authors compare cryopreservation of liver hepatocytes using STEM-CELLBANKER with the frequently used DMSO-University of Wisconsin (DMSO-UW) medium protocol. Both protocols yielded hepatocytes with good P450 function, however, the STEM-CELLBANKER protocol gave a higher viability than the DMSO-UW cryoprotectant. The researchers concluded that STEM-CELLBANKER beneficially is also xeno-free and will be applicable to cryopreservation of clinical-grade primary human hepatocytes...
In the article the authors compare cryopreservation of liver hepatocytes using STEM-CELLBANKER with the frequently used DMSO-University of Wisconsin (DMSO-UW) medium protocol. Both protocols yielded hepatocytes with good P450 function, however, the STEM-CELLBANKER protocol gave a higher viability than the DMSO-UW cryoprotectant. The researchers concluded that STEM-CELLBANKER beneficially is also xeno-free and will be applicable to cryopreservation of clinical-grade primary human hepatocytes... ImmunoPureTM PBMCs are a variety of immune cells derived from the peripheral blood of normal healthy human adult donors collected at IRB-approved blood banks. Seven types are currently available and consist of a variety of immune cells derived from the peripheral blood of normal adults, thereby qualifying them for a diverse number of cell-based experiments...
ImmunoPureTM PBMCs are a variety of immune cells derived from the peripheral blood of normal healthy human adult donors collected at IRB-approved blood banks. Seven types are currently available and consist of a variety of immune cells derived from the peripheral blood of normal adults, thereby qualifying them for a diverse number of cell-based experiments... Driven by the limitations of 2D cell cultures - scientists search for alternative solutions that mirror the environment experienced by normal cells in the body and replicate complex tissue structures and in vivo-like morphology. The '3D Cell Culture in Drug Discovery and Disease Modeling' webinar focuses on discussing the latest advances in 3D technology and its contribution to conducting more realistic research...
Driven by the limitations of 2D cell cultures - scientists search for alternative solutions that mirror the environment experienced by normal cells in the body and replicate complex tissue structures and in vivo-like morphology. The '3D Cell Culture in Drug Discovery and Disease Modeling' webinar focuses on discussing the latest advances in 3D technology and its contribution to conducting more realistic research... AMSBIO's custom generation of stable cell lines includes cloning the gene or shRNA of interest into a safe lentiviral vector, generating the lentivirus and transducing into the cell line of your choice. The service allows you to choose a constitutive or inducible promoter, a tag, an antibiotic selection marker and a fluorescent marker. The ease of providing your target templates or choosing one from AMSBIO's cDNA collection ensures rapid turnaround.
AMSBIO's custom generation of stable cell lines includes cloning the gene or shRNA of interest into a safe lentiviral vector, generating the lentivirus and transducing into the cell line of your choice. The service allows you to choose a constitutive or inducible promoter, a tag, an antibiotic selection marker and a fluorescent marker. The ease of providing your target templates or choosing one from AMSBIO's cDNA collection ensures rapid turnaround.
 The past few years have seen a boom in the number of papers published covering 3D cell culture, as researchers working in areas from cancer research to stem cells are increasingly seeing the benefits of this technique. AMSBIO supplies the most advanced and extensive range of 3D tools to the life science community...
The past few years have seen a boom in the number of papers published covering 3D cell culture, as researchers working in areas from cancer research to stem cells are increasingly seeing the benefits of this technique. AMSBIO supplies the most advanced and extensive range of 3D tools to the life science community... The AMSBIO Cultrex® 3D Culture Cell Harvesting Kit is based on a non-enzymatic approach that prevents biochemical degradation during processing and overcomes the problems associated with extracting cells from 3D culture in BME or Laminin I. The quality of the harvested cells is ideal for Western blotting and RNA and DNA analysis. In 3D culture, cells are grown in a microenvironment of specialized proteins that mimics in vivo conditions and allows the cells to organise into complex structures rather than uniform monolayers...
The AMSBIO Cultrex® 3D Culture Cell Harvesting Kit is based on a non-enzymatic approach that prevents biochemical degradation during processing and overcomes the problems associated with extracting cells from 3D culture in BME or Laminin I. The quality of the harvested cells is ideal for Western blotting and RNA and DNA analysis. In 3D culture, cells are grown in a microenvironment of specialized proteins that mimics in vivo conditions and allows the cells to organise into complex structures rather than uniform monolayers... AMSBIO provides an extensive portfolio of bromodomains and kits suitable for bromodomain profiling, inhibitor screening assays, and drug discovery. Bromodomains (BRDs) are 110 amino acid long domains that are found in many chromatin associated proteins. Bromodomains can interact specifically with acetylated lysine...
AMSBIO provides an extensive portfolio of bromodomains and kits suitable for bromodomain profiling, inhibitor screening assays, and drug discovery. Bromodomains (BRDs) are 110 amino acid long domains that are found in many chromatin associated proteins. Bromodomains can interact specifically with acetylated lysine... AMSBIO has expanded its range of rat specific ELISA kits that enable precise analysis of key neurodegenerative-related biomarkers while minimizing the use of precious samples. Visitors to the recent Neuroscience 2011 meeting in Washington DC responded enthusiastically to AMSBIO's range of over 2300 rat specific ELISA kits tailored for the sensitive and specific quantification of your cytokine, growth factor, or chemokine of interest. Particular interest was shown in new rat specific analyte ELISA kits for various Neurotrophins, TGFb1 and rat leptin as well as a series of ganglioside ELISAs...
AMSBIO has expanded its range of rat specific ELISA kits that enable precise analysis of key neurodegenerative-related biomarkers while minimizing the use of precious samples. Visitors to the recent Neuroscience 2011 meeting in Washington DC responded enthusiastically to AMSBIO's range of over 2300 rat specific ELISA kits tailored for the sensitive and specific quantification of your cytokine, growth factor, or chemokine of interest. Particular interest was shown in new rat specific analyte ELISA kits for various Neurotrophins, TGFb1 and rat leptin as well as a series of ganglioside ELISAs... AMSBIO has written an informative technical article to enable neuroscience researchers to learn more about a new method to control and direct differentiation of physiologically relevant neural cell types using stem cell qualified reagents. Stem cells have revolutionized our approaches to and understanding of neuroscience. The key to research success is the ability to control and direct differentiation into physiologically relevant neural cell types...
AMSBIO has written an informative technical article to enable neuroscience researchers to learn more about a new method to control and direct differentiation of physiologically relevant neural cell types using stem cell qualified reagents. Stem cells have revolutionized our approaches to and understanding of neuroscience. The key to research success is the ability to control and direct differentiation into physiologically relevant neural cell types... AMSBIO has added mouse Leukemia Inhibitory Factor (mLIF) to its extensive range of stem cell research products. Functionally tested with mouse ES cells, the affordably-priced AMSBIO recombinant mLIF combines both high quality and high activity. Mouse Leukemia Inhibitory Factor is a lymphoid factor involved in a number of biological processes including neural and hematopoietic cell differentiation, bone and fat metabolism, and mitogenesis of certain factor dependent cell lines...
AMSBIO has added mouse Leukemia Inhibitory Factor (mLIF) to its extensive range of stem cell research products. Functionally tested with mouse ES cells, the affordably-priced AMSBIO recombinant mLIF combines both high quality and high activity. Mouse Leukemia Inhibitory Factor is a lymphoid factor involved in a number of biological processes including neural and hematopoietic cell differentiation, bone and fat metabolism, and mitogenesis of certain factor dependent cell lines... AMSBIO have added a major new suite of video presentations and a bibliography of downloadable technical papers that demonstrate the utility of alvetex® - a unique synthetic scaffold that enables routine 3D cell culture. alvetex® is a highly porous polystyrene scaffold engineered into a 200µm thick membrane which provides a 3D space into which cells can invade, proliferate and grow. The vertical axis of the third dimension enables additional layers of cells to form complex 3D interactions...
AMSBIO have added a major new suite of video presentations and a bibliography of downloadable technical papers that demonstrate the utility of alvetex® - a unique synthetic scaffold that enables routine 3D cell culture. alvetex® is a highly porous polystyrene scaffold engineered into a 200µm thick membrane which provides a 3D space into which cells can invade, proliferate and grow. The vertical axis of the third dimension enables additional layers of cells to form complex 3D interactions... AMSBIO has introduced GeneInTM - a new transfection reagent specifically designed to transfect stem cells and primary cells. Comparative studies against other commercially available reagents show GeneInTM to be superior in transfection efficiency with minimum cytotoxicity...
AMSBIO has introduced GeneInTM - a new transfection reagent specifically designed to transfect stem cells and primary cells. Comparative studies against other commercially available reagents show GeneInTM to be superior in transfection efficiency with minimum cytotoxicity... STEM-CELLBANKER® from AMSBIO is a chemically defined freezing medium with optimized formulation for stem cells and iPS cells storage as well as other valuable cells. Supplied ready-to-use with a simple usage protocol, STEM-CELLBANKER® is completely free of serum and animal derived components, and contains only European or US Pharmacopoeia graded ingredients...
STEM-CELLBANKER® from AMSBIO is a chemically defined freezing medium with optimized formulation for stem cells and iPS cells storage as well as other valuable cells. Supplied ready-to-use with a simple usage protocol, STEM-CELLBANKER® is completely free of serum and animal derived components, and contains only European or US Pharmacopoeia graded ingredients... AMSBIO has announced a package of initiatives to support the Glycobiology research community following the recent announcement by Seikagaku Corporation that they plan to discontinue their research reagents and glycobiology biochemicals business as of September 30th 2011...
AMSBIO has announced a package of initiatives to support the Glycobiology research community following the recent announcement by Seikagaku Corporation that they plan to discontinue their research reagents and glycobiology biochemicals business as of September 30th 2011... AMSBIO announces ec23®* - a stable synthetic retinoid that has been proven in independent testing** to potently induce and reliably control stem cell differentiation. Stem cells self renew and have the ability to differentiate into a variety of cell types. They represent a valuable renewable resource from which functional tissues can be derived. Such materials can subsequently be used for research, disease modeling, drug testing and ultimately therapeutic applications...
AMSBIO announces ec23®* - a stable synthetic retinoid that has been proven in independent testing** to potently induce and reliably control stem cell differentiation. Stem cells self renew and have the ability to differentiate into a variety of cell types. They represent a valuable renewable resource from which functional tissues can be derived. Such materials can subsequently be used for research, disease modeling, drug testing and ultimately therapeutic applications... AMSBIO has announced the launch of the PluriPCRTM Kit, a new benchmark to revolutionize the definition of stem cell pluripotency. The PluriPCR kit has been designed as a quantitative, easy to use, and reliable assay of five genes strongly specific to pluripotency. These genes: Oct-3/4, Nanog, DNMT3b, Dppa4, and Rex1 are expressed by human embryonic stem cells (hESC) and induced pluripotent stem cells (iPSC); all are sharply down-regulated during differentiation.
AMSBIO has announced the launch of the PluriPCRTM Kit, a new benchmark to revolutionize the definition of stem cell pluripotency. The PluriPCR kit has been designed as a quantitative, easy to use, and reliable assay of five genes strongly specific to pluripotency. These genes: Oct-3/4, Nanog, DNMT3b, Dppa4, and Rex1 are expressed by human embryonic stem cells (hESC) and induced pluripotent stem cells (iPSC); all are sharply down-regulated during differentiation. AMSBIO is a leading supplier of Mouse Embryonic Fibroblasts (MEFs) and Newborn Human Foreskin Fibroblasts (NuFFs) for mouse and human pluripotent stem cell culture (ES and iPS cells). All AMSBIO feeder cell products are meticulously derived and comprehensively tested on mouse and human ES stem cells to ensure robust and consistent performance with every lot...
AMSBIO is a leading supplier of Mouse Embryonic Fibroblasts (MEFs) and Newborn Human Foreskin Fibroblasts (NuFFs) for mouse and human pluripotent stem cell culture (ES and iPS cells). All AMSBIO feeder cell products are meticulously derived and comprehensively tested on mouse and human ES stem cells to ensure robust and consistent performance with every lot... AMSBIO has announced the launch of Alvetex® - a unique cell culture scaffold that, for the first time, enables genuine 3D cell culture to be grown routinely and cost-effectively. Already successfully applied to numerous applications including drug toxicity models with liver cells, skin raft assays and bone remodeling studies - Alvetex® provides a stable and inert scaffold for cells to grow, mimicking in vivo growth and formation of tissues in the body...
AMSBIO has announced the launch of Alvetex® - a unique cell culture scaffold that, for the first time, enables genuine 3D cell culture to be grown routinely and cost-effectively. Already successfully applied to numerous applications including drug toxicity models with liver cells, skin raft assays and bone remodeling studies - Alvetex® provides a stable and inert scaffold for cells to grow, mimicking in vivo growth and formation of tissues in the body... New independent research demonstrates that the OrisTM Cell Migration Assay presents a superior quantitative, high throughput alternative to the scratch assay. Cell migration is integral to many physiological processes, including embryonic development, tissue regeneration, and wound healing. One assay commonly used to study cell migration is the scratch assay creating a cell-free gap, or "scratch", on a confluent cell monolayer...
New independent research demonstrates that the OrisTM Cell Migration Assay presents a superior quantitative, high throughput alternative to the scratch assay. Cell migration is integral to many physiological processes, including embryonic development, tissue regeneration, and wound healing. One assay commonly used to study cell migration is the scratch assay creating a cell-free gap, or "scratch", on a confluent cell monolayer... AMSBIO has announced a new range of highly efficient knockdown cell lines covering the Base Excision DNA Repair pathway. The new range of 20 DNA Repair Knockdown cell lines was developed to enable scientists to study the molecular etiology of tumour genomic instability and to exploit it in oncology research. The AMSBIO DNA Repair Knockdown cell lines are based upon target-specific LN428 glioblastoma shRNA lentivirus transduced cells that are rigorously qualified and mycoplasma free.
AMSBIO has announced a new range of highly efficient knockdown cell lines covering the Base Excision DNA Repair pathway. The new range of 20 DNA Repair Knockdown cell lines was developed to enable scientists to study the molecular etiology of tumour genomic instability and to exploit it in oncology research. The AMSBIO DNA Repair Knockdown cell lines are based upon target-specific LN428 glioblastoma shRNA lentivirus transduced cells that are rigorously qualified and mycoplasma free. AMSBIO has announced the launch of ecoHSA - an animal-free preparation of the human albumin gene produced in the seeds of Asian Rice (Oryza sativa). Commercial human albumin proteins extracted from plasma have multiple and invaluable uses in cell culture work.
AMSBIO has announced the launch of ecoHSA - an animal-free preparation of the human albumin gene produced in the seeds of Asian Rice (Oryza sativa). Commercial human albumin proteins extracted from plasma have multiple and invaluable uses in cell culture work. GenePORTER® Gold from AMSBIO is a new highly efficient and reproducible lipid-based reagent for effective transfection of a wide variety of cell lines. Molecular target delivery faces many barriers, from crossing the cell type-specific extracellular membrane, to cytoplasmic degradation and translocation across the nuclear membrane. To be effective, the transfection reagent/DNA complexes must overcome all of these challenges whilst minimizing cytotoxicity
GenePORTER® Gold from AMSBIO is a new highly efficient and reproducible lipid-based reagent for effective transfection of a wide variety of cell lines. Molecular target delivery faces many barriers, from crossing the cell type-specific extracellular membrane, to cytoplasmic degradation and translocation across the nuclear membrane. To be effective, the transfection reagent/DNA complexes must overcome all of these challenges whilst minimizing cytotoxicity AMSBIO is now able to offer a range of over 4,000 full length affinity purified human proteins expressed in HEK293 cells and derived using an extensive collection of human cDNA clones. The new range is currently the broadest offering of human proteins produced in human cells. It has been prepared to ensure optimal preservation of protein structure, post-translational modifications and functions.
AMSBIO is now able to offer a range of over 4,000 full length affinity purified human proteins expressed in HEK293 cells and derived using an extensive collection of human cDNA clones. The new range is currently the broadest offering of human proteins produced in human cells. It has been prepared to ensure optimal preservation of protein structure, post-translational modifications and functions. The AMSBIO range of Universal Reference Products (RNA, cDNA and Protein Lysate) has been expanded to include standards for studies involving humans as well as for animal species including Monkey, Dog, Mouse, Rat, and Chicken. These products provide ideal controls for high throughput PCR, RNA microarray and antibody array studies
The AMSBIO range of Universal Reference Products (RNA, cDNA and Protein Lysate) has been expanded to include standards for studies involving humans as well as for animal species including Monkey, Dog, Mouse, Rat, and Chicken. These products provide ideal controls for high throughput PCR, RNA microarray and antibody array studies ExpressArt® mRNA Amplification Kits from AMSBIO offer an elegant technological solution for qRT-PCR and gene expression array studies that overcomes the limitations of sample quality and quantity. ExpressArt® technology allows reproducible and precise analysis of challenging samples including Formalin-Fixed Paraffin-Embedded (FFPE), laser captured micro-dissections, needle biopsies, and circulating tumor cells.
ExpressArt® mRNA Amplification Kits from AMSBIO offer an elegant technological solution for qRT-PCR and gene expression array studies that overcomes the limitations of sample quality and quantity. ExpressArt® technology allows reproducible and precise analysis of challenging samples including Formalin-Fixed Paraffin-Embedded (FFPE), laser captured micro-dissections, needle biopsies, and circulating tumor cells. AMSBIO has announced new kits for the isolation of high quality RNA from Formalin-Fixed Paraffin-Embedded (FFPE) tissues and LCM samples that can be applied both to qRT-PCR and a variety of microarray platforms.
AMSBIO has announced new kits for the isolation of high quality RNA from Formalin-Fixed Paraffin-Embedded (FFPE) tissues and LCM samples that can be applied both to qRT-PCR and a variety of microarray platforms. AMSBIO has announced an expanded range of assay kits and reagents for the detection and analysis of apoptosis. A new selection guide has been created by AMSBIO to provide researchers with a quick and easy way to identify and select the best tools to measure apoptosis.
AMSBIO has announced an expanded range of assay kits and reagents for the detection and analysis of apoptosis. A new selection guide has been created by AMSBIO to provide researchers with a quick and easy way to identify and select the best tools to measure apoptosis. AMSBIO has announced the launch of the first of a new generation of cell migration assays designed specifically for fully automated high throughput screening (HTS) utilizing high content screening (HCS) and high content imaging (HCI) systems.
AMSBIO has announced the launch of the first of a new generation of cell migration assays designed specifically for fully automated high throughput screening (HTS) utilizing high content screening (HCS) and high content imaging (HCI) systems.
 AMSBIO has announced Solu BL21TM Competent E. coli, a significantly improved BL21 host strain for soluble mammalian protein expression. Using a directed evolution approach, a mutant strain of BL21(DE3) E. coli has been developed that can produce soluble protein in the majority of cases where expression in the parent BL21(DE3) yielded no detectable soluble product.
AMSBIO has announced Solu BL21TM Competent E. coli, a significantly improved BL21 host strain for soluble mammalian protein expression. Using a directed evolution approach, a mutant strain of BL21(DE3) E. coli has been developed that can produce soluble protein in the majority of cases where expression in the parent BL21(DE3) yielded no detectable soluble product.